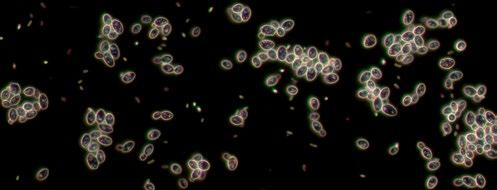

FORUM BRAUEREI
Fachzeitschrift für Brauereien, Mälzereien, Getränkeindustrie und deren Partner
Ausgabe 4 | 26. April 2024 | 39. Jahrgang | ISSN 0179-2466


Fachzeitschrift für Brauereien, Mälzereien, Getränkeindustrie und deren Partner
Ausgabe 4 | 26. April 2024 | 39. Jahrgang | ISSN 0179-2466


Die Welt verändert sich. Wie gut sind Sie auf potenzielle Risiken in Ihrer Hopfenversorgung vorbereitet? Machen Sie den Test.








Ernte Schwankungen Hohe Produktionskosten
Verschärfte Vorschriften

Mehr über die Risikofaktoren und wie Sie Ihr Unternehmen schützen können, erfahren Sie unter barthhaas.com/risiko












Hier geht‘s zu Ihrer RisikoAnalyse



Laborinstrumente und mikrobiologische Nährmedien für die Analyse von Rohstoffen, Zwischen- und Endprodukten sowie Nebenprodukten für
Symposium for craft and micro brewers from Germany & European countries
7 November 2016, Nuremberg, Germany
MENSCHEN & UNTERNEHMEN
4 VLB Aktuell: Innovationstag Mittelstand des BMWK 2024 in Berlin: Die VLB ist dabei / Karlsberg Brauerei: Große Nachfrage nach neuer Unternehmensanleihe
5 VLB-Braumeister Jacques Dahnke wird neuer Direktor der Wernesgrüner Brauerei / Verein Münchener Brauereien: Dr. Martin Leibhard wird neuer Vorsitzender
6 VLB-Tagungen in Groningen und Chemnitz mit großem Zuspruch
TECHNIK & TECHNOLOGIE
8 Intelligente Verpackungslösung: Estrella Galicia setzt auf KHS
9 BarthHaas-Grant 2024: Bewerbungsfrist endet am 31. Juli
10 Brauer-Schule – Fachfragen und Fachrechnen für Auszubildende: Flaschenreinigung
11 Elektromobilität: Berliner-Kindl-Schultheiss-Brauerei nimmt elektrisch Fahrt auf
12 VLB-Frühjahrstagung 2024: Klimaneutralität in der Brauindustrie ist Herausforderung und Chance zugleich
15 VLB-Logistikfachkongress feiert Jubiläum: Die 25. Auflage fand in Chemnitz statt
IfGB AKTUELL
18 Prämierungen: Craft Spirits Berlin Awards 2024 verliehen
19 Der 1. Kurs zum VLB-Bier- und Spirituosen-Sommelier ist gestartet
20 Qualität: DLG-Spirituosenverkostung in Gau-Bickelheim
21 Personalia: DLG verabschiedet Ralf Hapke / Max-Eyth-Denkmünze der DLG für Dr. Richard Nusser
22 Brau-Börsen-Bilanz: Internationale Braukonzerne geben 2023 Absatz ab
MARKT & MARKEN
26 Nachrichten: Radeberger Pilsner startet mit neuem Auftritt in die Zukunft / C. & A. Veltins: Das Helle Lager schafft Erfrischungs-Genuss in der 0,275-l-Flasche
27 AB InBev ist neuer Bierpartner von Hertha BSC
28 Spaten Brauerei: „Seit 130 Jahren offiziell, wir brauten’s erste Münchner Hell“ / Haus Cramer Gruppe: Oberbräu Hell interpretiert seine bayerische Brautradition neu
INSTITUTIONEN & VERBÄNDE
29 Das Brauring-Braumeister-Seminar fand in Zusammenarbeit mit VLB Berlin statt / GfH: Jahreshauptversammlung – Nachhaltigkeit in der Hopfenproduktion im Fokus
30 Vereinigung ehem. VLBer – Brewers of Berlin: Einladung zur ordentlichen Mitgliederversammlung / Einladung zum VLB-Sommerfest 2024
SONSTIGES
31 Stellenanzeigen der VLB Berlin / Lösungen Brauer-Schule / Impressum
32 Veranstaltungskalender

Das kann sich sehen lassen: Insgesamt nahmen rund 500 Teilnehmer an der 108. Frühjahrstagungder VLB Berlin in Groningen und am 25. VLBLogistikfachkongress in Chemnitz teil

Die Berliner-Kindl-SchultheissBrauerei schickt ihre ersten batteriebetriebenen Lkw auf die Straße, um die weitere Dekarbonisierung der Logistik voranzutreiben 11

Mitte April startete die Weiterbildung zum Bier- und Spirituosensommelier. Die Weiterbildung ist eine Kooperation zwischen der VLB Berlin, dem IfGB und dem Michelberger Hotel 19

Am 5. Juli ist es wieder so weit: Auch in diesem Jahr veranstaltet die VLBBerlin ihr legendäres Sommerfest – unterstützt von der Vereinigung ehem. VLBer, die vor dem Fest zur Mitgliederversammlung einladen
Beim Innovationstag Mittelstand des Bundesministeriums für Wirtschaft und Klimaschutz (BMWK) am 13. Juni in Berlin präsentiert sich der innovative Mittelstand als treibende Kraft der deutschen Wirtschaft. Unter dem Leitgedanken „So geht Zukunft! – Digital. Transformativ. Resilient.“ präsentieren rund 300 Aussteller – darunter auch die VLB Berlin – Er-


gebnisse ihrer zukunftsweisenden Forschungs- und Entwicklungsprojekte.
(oh) Auch die VLB Berlin als aktiver Forschungspartner der Brau- und Getränkewirtschaft ist in diesem Jahr wieder mit einem Stand vertreten. Vorgestellt werden die Ergebnisse des Projektes „Alterungsstabilität heller Vollbiere“ (IGF 20151 N) des VLB-Forschungsinstituts für Bier- und Getränkeanalytik. Neben den wissenschaftlichen Erkenntnissen werden dabei auch praktische Beispiele präsentiert. Neben einem umfangreichen Informations- und Beratungsangebot zur Unterstützung innovativer Ideen durch die zahlreichen Förderinitiativen und -programme des BMWK wird der Innovationstag auch Gelegenheit bieten, in sommerlichem Ambiente mit Vertreterinnen und Vertretern aus Wirtschaft, For-
schung und Politik ins Gespräch zu kommen.
Ebenfalls auf der Agenda des Events: eine International Area mit Angeboten zur Unterstützung internationaler Kooperationen, geführte Rundgänge über das Ausstellungsgelände und ein facettenreiches Bühnenprogramm mit Impulsen zu innovationspolitischen Themen. Außerdem gibt es Speed-PitchSessions zu den Themen „Digital: Künstliche Intelligenz in der Praxis“, „Transformativ: Technologien im Wandel“ und „Resilient: Innovationen für mehr Sicherheit“.
Die im Auftrag des BMWK von der AiF Projekt GmbH organisierte Open-Air-Veranstaltung am 13. Juni 2024 in der Tschaikowskistraße 49 in 13156 Berlin-Pankow beginnt um 10:00 Uhr, Einlass ist ab 9:00 Uhr. Der Besuch ist kostenfrei. Infos und Anmeldung: innovationstagmittelstand-bmwk.de
Karlsberg Brauerei
Die neue Unternehmensanleihe der Karlsberg Brauerei GmbH 2024/2029 mit einem jährlichen Zinssatz von 6 % ist sowohl bei Inhabern der bestehenden Anleihe 2020/2025 als auch bei institutionellen Investoren, Vermögensverwaltern und bei Privatanlegern auf großes Interesse gestoßen. Daher wurde die Zeichnungsfrist verkürzt.
(F) Aufgrund der starken Nachfrage wurden die Fristen für den Umtausch und die Neuzeichnung verkürzt und sind am 18./19. April ausgelaufen. Die neue Anleihe 2024/2029 hatte ein Zielvolumen von 50 Mio. € bei einer Laufzeit von fünf Jahren. Der jährliche feste Zinssatz wurde auf 6,00 % festgelegt und soll halbjährlich nachträglich ausgezahlt werden.

Die Notierungsaufnahme der neuen Anleihe an der Frankfurter Wertpapierbörse im Segment Quotation Board (Open Market) ist für den 2. Mai 2024 vorgesehen.
Die Emittentin beabsichtigt, innerhalb von drei Geschäftstagen nach dem Ausgabetag (Valuta) der neu -
en Anleihe 2024/2029 von ihrem Kündigungsrecht für die Anleihe 2020/2025 Gebrauch zu machen und alle im Rahmen des Umtauschangebots 2024 nicht eingereichten, ausstehenden Schuldverschreibungen bis spätestens 6. Juni 2024 zurückzuzahlen.
Jacques Dahnke übernahm mit Wirkung zum 1. April 2024 die Geschäftsführung der Wernesgrüner Brauerei und folgte damit auf den bisherigen Brauereidirektor Dr. Marc Kusche, der das Unternehmen nach einer Übergangsphase Ende März verlässt und die Karriere in seiner alten Heimat Bayern fortsetzt.
(F.) Der zuletzt in der Schweiz als Director Utilities & ISC TTZ Group tätige Jacques Dahnke blickt bereits auf eine lange Karriere innerhalb der Carlsberg Gruppe zurück, in der er Erfahrungen sowohl in der europäischen als auch der asiatischen Brauindus trie sammeln konnte. Der Mittdreißiger begann 2007 bei Carlsberg Deutschland mit der Ausbildung zum Brauer und Mälzer in der Mecklenburgischen Brauerei Lübz und schloss weiterführend als Braumeister an der VLB Berlin ab. Nach seiner Ausbildung sammelte er in Lübz Produktions-Erfahrung
als Brauer und Teamleiter. 2015 wechselte er als Supply Chain Development Manager zu Carlsberg China in Guang zhou, wo er eine bedeutende Rolle bei der erfolgreichen Inbetriebnahme der Dali Greenfield Brauerei einnahm. Im Januar 2017 wurde er zum Utilities Manager ernannt und erweiterte im Oktober 2019 sein Aufgabengebiet um den asiatischen Markt. Anschließend kehrte Dahnke dann zurück nach Europa. Für seine neue Aufgabe als Wernesgrüner Brauereidirektor wird er mit seiner Familie von der Schweiz nach Dresden ziehen. Simon Mosegaard Fibiger, CEO bei Carlsberg Deutschland, begrüßt die NeuBesetzung: „Ich bin froh, dass wir mit Jacques einen sehr versierten und technisch kompetenten Nachfolger für Marc Kusche gefunden haben. Von besonderer Bedeutung ist auch seine Erfahrung auf dem Gebiet der Effizienzsteigerung, die bei der Zielerreichung unseres am -
bitionierten Nachhaltigkeitsprogramms ‚Together Towards ZERO and Beyond‘ sicher einen entscheidenden Mehrwert liefern wird. Ich bin überzeugt, dass er als Mensch, Experte und Führungskraft zum WernesgrünerTeam passt.“
Jacques Dahnke freut sich über die Rückkehr zu seinen beruflichen Wurzeln bei Carlsberg Deutschland: „Die Wernesgrüner Brauerei blickt auf eine beeindruckende Brauhistorie zurück, das ist etwas Besonderes. Es ist für mich ein großartiges Gefühl, nach einer langen Zeit im Ausland wieder in meiner Heimat Deutschland zu sein und ich bin voller Vorfreude, die Zukunft der Wernesgrüner Brauerei gemeinsam mit den Kolleginnen und Kollegen auch weiterhin erfolgreich zu gestalten.“

Jacques Dahnke hat zum 1. April die Führung der zur Carlsberg Gruppe gehörenden Wernesgrüner Brauerei übernommen
Verein Münchener Brauereien e.V.
Augustiner-Geschäftsführer Dr. Martin Leibhard übernimmt den Vorsitz des Vereins Münchener Brauereien. Die Vertreter der sechs Traditionsbrauereien wählten ihn am 20. März im Rahmen der Mitgliederversammlung einstimmig.
(F.) Dr. Martin Leibhard tritt die Nachfolge von Andreas Steinfatt an, der die Paulaner Geschäftsführung verlassen und damit auch den Vorsitz des Vereins Münchener Brauereien abgegeben hat.
Dr. Martin Leibhard ist seit 2014 Geschäftsführer der AugustinerBräu Wagner KG. Der gebürtige Münchener, dessen Vater bereits Technischer Direktor bei Augustiner war, hat eine Ausbildung zum Brauer und Mälzer sowie ein Studium im Fach Brauwesen und Geträn -
ketechnologie in Weihenstephan absolviert und dort promoviert. Nach Stationen als Berater für die Brau- und Getränkeindustrie sowie Geschäftsführer bei der Tucher Bräu wechselte Leibhard zur INKAHolding, wo er bis heute ebenfalls als Geschäftsführer tätig ist. Im Verein Münchener Brauereien war er bisher als offizieller Vertreter der Augustiner-Bräu Wagner KG präsent.
„Den Verein Münchener Brauereien in die Zukunft zu führen und seine lange Tradition als zentrale Basis und Triebkraft der Münchener Brauwirtschaft fortzuschreiben, ist eine spannende Aufgabe“, so Dr. Martin Leibhard. „Vor allem als gelernter Brauer und Mälzer ist es mir eine Ehre, das prägende Handwerk unserer Stadt und unsere Bierkultur zu vertreten. Ich freue mich auf eine
gute und enge Zusammenarbeit mit der Stadt München.“ Geschäftsführer Andreas Maisberger betont:
„Mit Dr. Martin Leibhard übernimmt einer der erfahrensten und profiliertesten Vertreter der Münchener Brauwirtschaft. Damit ist eine ideale Nachfolge für Andreas Steinfatt gefunden, dessen Abschied wir sehr bedauern. Mit ihm geht eine der großen Persönlichkeiten des Münchener Brauwesens. Der Verein dankt Andreas Steinfatt für seine großen Verdienste um das Kulturgut Münchener Bier, für das er sich über viele Jahre mit Herz und Leidenschaft stark gemacht hat.“
Dr. Martin Leibhard folgt auf Andreas Steinfatt als Vorsitzender des Vereins Münchener Brauereien

Rund 320 Teilnehmer bei der 108. Brewing & Engineering Conference der VLB Berlin im niederländischen Groningen und 160 Fachbesucher beim 25. VLB-Logistikfachkongress in Chemnitz – so die eindrucksvolle Bilanz der beiden VLB-Tagungen, die jedes Jahr im März stattfinden.
(oh) Die VLB-Frühjahrstagung, die vom 13. bis 15. März im MartiniPlaza Event Center in Groningen, NL, stattfand, stand in diesem Jahr unter dem Motto “Brewing Industry is moving towards Net Zero – Status and Prospects”. An zwei Vortragstagen stellten die Royal Swinkels Family Brewers, Carlsberg New Technologies & Carlsberg Research, Heineken, die Technische Universität Berlin, die Grolsche Bierbrou -
Fotos:
1 + 2 Groningen: Spannende Vorträge trafen auf ein sehr interessiertes Publikum
3 Eemshaven: Die Mälzerei von Holland Malt direkt am Hafen (am Kai links vor dem Turm das Festzelt)
4 Eemshaven: Holland Malt-CEO Jos Jennissen (r.) und Johan Hamster, Abgeordneter der Provinz Groningen für Klima, Energie, Wasser und Mobilität, drehen den Gashahn zu
5 Eemshaven: Mehr als 400 Gäste bei der Eröffungsparty in Eemshaven
6 Chemnitz: Jubiläum – der 25. VLB-Logistikfachkongress
7 + 8 Chemnitz: Vortrag und Besichtigung der Produktion von Bleisäure- und Lithiumionen-Batterien bei Triathlon in Glauchau


werij, die Bitburger Braugruppe sowie Krones, GEA, Pentair, Herco Wassertechnik, RWE und die VLB Berlin Konzepte und Erfahrungen zur nachhaltigen Gestaltung der Zukunft der Braubranche zur Diskussion. Weitere Veranstaltungspunkte waren die turnusmäßige Sitzung des Technisch-Wissenschaftlichen Ausschusses (TWA) der VLB, die begleitende Fachausstellung, das Get-together am ersten Abend und natürlich die feierliche Eröffnung der emissionsfreien Mälzerei von Holland Malt in Eemshaven.
Klimaneutralität als strategisches Unternehmensziel Im dem hochkarätig besetzten Vortragsprogramm stellten unter anderem Carlsberg, Heineken, Grolsch, Swinkels Family Brewers und die Bitburger Braugruppe ihre Konzepte und Wege zur Umstellung auf nachhaltige Produktion vor. Es wurde deutlich, dass die Konversion in Richtung CO2-neutraler Pro -
duktion bereits in voller Fahrt ist: „Sustainable production is not an option – it’s a must“, lautete auch ein gemeinsamer Nenner der Referenten (s. S. 12).
Einer der Höhepunkte der Tagung war die Exkursion von Groningen in das 30 km entfernte Eemshaven an der Nordseeküste. Dort betreibt Holland Malt seit etwa 20 Jahren eine große Mälzerei mit vier Türmen und einer Produktionskapazität von jährlich rund 280 000 t Malz. Mit dem Ziel, die CO2-Emissionen bei der Malzherstellung drastisch zu reduzieren, wurde dort die gesamte Beheizung der Darren von Erdgas auf Wärmepumpen umgestellt und im Rahmen der Besichtigung feierlich in Betrieb genommen. Während des Besuchs am 14. März wurden mehr als 400 Besucher durch alle Bereiche der laufenden Mälzerei geführt. Im Anschluss rundete eine opulente Eröffnungsparty auf dem Werksgelände die Exkursion nach Eemshaven ab.




VLB-Geschäftsführer Dr. Josef Fontaine: „Ingesamt war unsere Frühjahrstagung in Groningen und Eemshaven sicherlich eines der Jahres-Highlights unserer Branche, das kaum mehr zu toppen ist. Wir bedanken uns bei Holland Malt und den Royal Swinkels Family Brewers für die tolle Unterstützung!“
Die nächste VLB-Frühjahrstagung ist für März 2025 geplant.
25. VLB-Logistikfachkongress: Jubiläumsveranstaltung in Chemnitz
Zum 25. Mal lud die VLB zu ihrem Logistikfachkongress ein, der vom 4. bis 6. März im sächsischen Chemnitz stattfand. Rund 160 Teilnehmer diskutierten über Trends in der Getränkelogistik. Eine Besichtigung der Batterieproduktion der Triathlon Batterien GmbH in Glauchau rundete die Veranstaltung ab.
Der Logistikfachkongress der VLB Berlin ist seit 1998 ein fester Termin im Kalender vieler Getränkelogistiker. Er fokussiert sich auf aktuelle technische und logistische Themen rund um den Bereich der Intra- und Transportlogistik in der Brau- und Getränkeindustrie sowie dem Getränkefachgroßhandel. Die diesjährige Veranstaltung begann mit


der Sitzung des Fachausschusses für Logistik des Betriebswirtschaftlichen Ausschusses (BWA) der VLB Berlin. An den beiden darauffolgenden Vortragstagen standen Themen wie Digitalisierung und KIEinsatz in der Getränkeindustrie, Automatisierung der Intralogistik sowie nachhaltige Logistikoptimierung auf der Agenda. Die Getränkebranche ist bereits gut aufgestellt, aber es gibt immer wieder vielversprechende Ansätze für weitere Optimierungen – so der Tenor vieler Referenten (s. S. 15). Das Vortragsprogramm wurde ergänzt durch eine Besichtigung des Werks der Triathlon Batterien GmbH in Glauchau. Dort produziert das Unternehmen leistungsstarke Bleisäureund Lithiumionen-Batterien für den Einsatz in elektrisch betriebenen Flurförderzeugen, Elektrohubwagen, mobilen Hubarbeitsbühnen oder Reinigungsmaschinen.
Der 25. VLB-Logistikfachkongress war ein voller Erfolg und bekam im Nachgang auch viel positiven Zuspruch auf LinkedIn. Die VLB dankt insbesondere den beiden Sponsoren, Triathlon Group und STILL GmbH, für die Unterstützung.
Der 26. VLB-Logistikfachkongress ist für März 2025 geplant.

May 7/8, 2024, VLB Berlin (in English)
Sour fermented beverages are already shaping the beverage market today and will become more relevant in the future. VLB Berlin has many years of experience in the field of beverage development based on co-cultures as well as in the development and provision of corresponding starter cultures. Since 2019, we have been able to bring science, industry and authorities together in order to discuss the latest research results and practice-relevant findings on the production and regulation of various fermentation products.
Topics
+ Regulation, Claims, Beverage Development, Reproducibility & Shelf Life
+ Ingredients, Filtration, Kombucha
+ Business Development, NABLAB, Sensory
+ Kefir, R&D, Kombucha, Sweetener, SCOBY Microbiome
+ Stabilization, Trends, Biotics, Mineralization
Additional Programme:
+ Exhibition, Tour: Wilfried-Rinke Pilot Brewery, Get-Together
With support of:

www.vlb-berlin.org/en/safb2024
In ihrem Wachstumssegment der Getränkedose setzt die spanische Traditionsbrauerei Estrella Galicia gleich zweifach auf das Nature MultiPack von KHS. Damit entscheidet sie sich für „innovative Technologie und einen zuverlässigen Partner“.


(F.) Im äußersten Nordwesten Spaniens liegt die Region Galicien. Außer für ihre Hauptstadt Santiago de Compostela, Wallfahrtsort und Ziel des Jakobswegs, ist sie vor allem für ihr Klima bekannt. Nirgendwo sonst auf der iberischen Halbinsel regnet es öfter und mehr. Im Gegensatz zum teilweise von Dürren geplagten Rest des Landes erinnern die grünen Hügel und häufige Nebel an die irische Küste. Groß ist deshalb die Bedeutung von Landwirtschaft und Fischfang, auf dessen Vielfalt und Qualität die Galicier besonders stolz sind. Aus diesem Füllhorn schöpft auch Estrella Galicia, das in der Hafenstadt A Coruña ansässige Flaggschiff des Familienunternehmens Hijos de Rivera. Bekannt ist die viertgrößte Brauerei des Landes vor allem für ihr helles, goldenes Bier, das aus besonders herben Malzen und Hopfen hergestellt wird. Es benötigt mehr als 20 Tage zum Brauen, Gären und Reifen, was dem Bier seinen charakteristischen Hopfengeschmack verleiht. Man zeichnet sich aber auch durch große Experimentierfreude aus, wie Braumeister Luis Alvar berichtet: „Jährlich brauen wir drei bis vier Spezialitäten als limitierte Editionen. Wir haben unser Bier beispielsweise schon mit Kastanien, Kürbis oder Honig aromatisiert und sogar mit Entenmuscheln. Und unser Pimientos-de-Padron-Bier, dem wir die hier heimischen Paprika zusetzen, ist ein Hit.“
Modern und traditionell zugleich
Die handwerklich unter dem Namen „Fábrica de cerveza“ hergestellten Spezialbiere sind nur eines von vielen Beispielen für den Premiumanspruch des Unternehmens.
„In Abgrenzung zu den industriellen Großbrauereien Spaniens verstehen wir uns trotz unserer zuletzt rapide gewachsenen Größe noch als ein traditioneller Betrieb“, betont Alvar. „Wir setzen zwar modernste Technologie ein, aber immer unter dem Vorbehalt klassischer Verfahren. Ein gutes Produkt herzustellen kostet Zeit, und die nehmen wir uns.“ Abgesehen von den innovativen Produkten ist das unter dem Namen Estrella Galicia firmierende Lager weiterhin umsatzstärkstes Zugpferd. Dank überdurchschnittlicher Steigerungsraten befindet sich das Unternehmen auf Erfolgskurs –und sieht auch künftig erhebliches Wachstumspotenzial. Schließlich legt in Spanien seit einigen Jahren der Bierkonsum insgesamt kontinuierlich stark zu.
Weiter auf Expansionskurs Entsprechend ambitioniert sind die Pläne: Weil die bisherige Produktionsstätte Agrela in A Coruña mit neun Abfülllinien an ihre Kapazitätsgrenze stößt, investiert man derzeit 10 km vom gegenwärtigen Standort entfernt in eine neue Fabrik. Schon bald steht hier eine Fläche von insgesamt 500 000 m2 zur Verfügung, die Raum für weitere Expansion bietet. Einer der wichtigsten Technologiezulieferer von Hijos de Rivera ist das in Dortmund ansässige Unternehmen KHS. Insgesamt fünf Linien in den Behälterkategorien Glas, Getränkedose und Keg hat der Maschinen- und Anlagenbauer aus Deutschland bisher nach A Coruña geliefert. „Für uns ist KHS seit vielen Jahren einer unserer wichtigsten Partner“, betont Jesús Martínez Garcia, Betriebsleiter des Getränkeherstellers Hijos de Rivera. Zu den jüngsten gemeinsamen Projekten zählt etwa eine schlüsselfertige Dosenlinie mit einer Kapazität
von bis zu 72 000 Behältern pro Stunde. Teil dieser Anlage sind zwei Verpackungsmaschinen: Einerseits ein Innopack Kisters Nature MultiPacker für den Hochleistungsbereich, in der die Getränkebehälter ganz ohne Folie oder Karton nur durch leicht lösbare Klebepunkte zu Packs von vier oder sechs Dosen zusammengefasst werden. Darüber hinaus verfügt eine Innopack Kisters TSPP über ein Papiereinschlagmodul, das 12 bis 24 Behälter statt in Schrumpffolie in Papier wickelt und für eine exakte Faltung und Verleimung im Packprozess sorgt. Ziel beider Packer ist es, optimierte Lösungen mit möglichst geringem Materialverbrauch anzubieten und gleichzeitig den CO2-Fußabdruck der Verpackung signifikant zu verringern. Parallel wurde eine bereits bestehende KHS-Dosenlinie mit einem Durchsatz von bis zu 60 000 Behältern pro Stunde ebenfalls um einen Innopack Kisters Nature MultiPacker erweitert.
Verpackungslösung mit Alleinstellung
„Traditionell haben wir unsere Getränkedosen immer in Kartons verpackt, um keine Kunststofffolie verwenden zu müssen“, erklärt Martínez Garcia. „Angesichts der Umweltdiskussion rund um Verpackungen verzichten unsere Wettbewerber inzwischen zunehmend auf Folien- bzw. Hi-ConeGebinde und wenden sich ebenfalls Kartonagen zu. Uns ist es vor diesem Hintergrund wichtig, dass die Verpackungslösungen unserer Produkte im Markt weiterhin eine Besonderheit darstellen. Deshalb haben wir uns für das Nature MultiPack entschieden – eine Premiere im spanischen Markt.“
Die Einführung der neuartigen und nachhaltigen Alternative hat Hijos
de Rivera mit einer Marketingkampagne begleitet. Unter dem Motto „Die beste Verpackung ist die, die es nicht gibt“ firmiert das Sixpack von Estrella Galicia darin als NoPack. Dank der Werbung in Form von aufmerksamkeitsstarken Videos wurde die neue Lösung im Markt ausgezeichnet aufgenommen – so sehr, dass man den Erfolg an den Verkaufszahlen ablesen könne. „Ein wichtiger Teil unserer Aktivitäten dient der Ressourceneinsparung und der Verringerung des CO2Fußabdrucks“, betont der Betriebsleiter. „Das war einer der Gründe, warum wir uns auch bei unserer neuesten Dosenlinie für KHS entschieden haben. Der Maschinenund Anlagenbauer konnte bei uns nicht nur mit dem Linien-Layout, sondern auch mit dem niedrigsten Energieverbrauch im Markt punkten. Über die Implementierung be -
sonders energieeffizienter Technologien hinaus nutzen wir Methoden zur Energierückgewinnung. Und wir denken intensiv über die Verpackung unserer Produkte nach.“ Neben Sekundärverpackungen wie dem Nature MultiPack oder dem Papiereinschlag von KHS setzt man bei Estrella Galicia deshalb inzwischen bei der Primärverpackung verstärkt auf die Getränkedose: „Wir sind davon überzeugt, dass sie aufgrund ihrer Recyclingfähigkeit und ihres einfachen Handlings für die Verbraucher eine zunehmend größere Rolle spielen wird“, meint Martínez Garcia.
Verlässlicher Partner
„Mit KHS haben wir für diese Entwicklung den richtigen Technologieanbieter an unserer Seite“, findet Produktionsdirektor Carlos Bao. Besonders schätzt er die reibungslose

Abstimmung und Zusammenarbeit zwischen dem Projektteam einerseits und der Montage und Inbetriebnahme andererseits. Am wichtigsten sind für ihn der lokale Service und die Betreuung durch die spanische Niederlassung vor Ort.
Der Innopack Kisters von KHS wickelt Getränkedosen in Papier mit exakter Faltung und Verleimung.
BarthHaas-Grants 2024
Unter dem Titel „BarthHaas Grants“ will BarthHaas auch 2024 wieder zwei vielversprechende Forschungsansätze mit Stipendien in Höhe von jeweils 10 000 € fördern. Unterstützt werden Projektideen aus den Bereichen Brauwissenschaft und Hopfen. Junge Forscherinnen und Forscher können sich bis 31. Juli bei dem weltweit führenden Hopfendienstleister bewerben.
(F.) Der Antrag muss auf Englisch verfasst sein. Auf maximal zwei DIN-A4-Seiten sollen Titel und Fragestellung sowie der aktuelle Wissensstand und die Bedeutung der Arbeit für die Branche zusammengefasst und ein Lösungsweg skizziert werden. Förderungswürdig sind Projektideen. Forschungsprojekte, die bereits abgeschlossen sind, kommen nicht für ein Stipendium infrage. Die Bewerbungen nimmt Dr. Christina Schönberger, Leiterin BarthHaas Campus, unter der E-Mail christina.schoenberger@barthhaas.com entgegen.
Über die eingereichten Anträge entscheidet das Scientific Committee von BarthHaas.
Mit den BarthHaas Grants werden seit 2007 jährlich richtungsweisende wissenschaftliche Projekte an Hochschulen, Universitäten und Forschungseinrichtungen gefördert. In vielen Fällen dienten sie als Anschubfinanzierung. Denn viele erfolgreiche Arbeiten erweckten breite Aufmerksamkeit und konnten mit öffentlichen Mitteln fortgeführt werden. Mit den Grants will BarthHaas Begeisterung für den Hopfen wecken, Forschungsideen fördern und nicht zuletzt auch Kontakte zu jungen, vielversprechenden Wissenschaftlern aufbauen und intensivieren. In den vergangenen Jahren hat sich, auch angeschoben durch die weltweite CraftbierBewegung, in der Hopfen -
forschung viel getan. Beispielsweise in der Aromaforschung haben die von BarthHaas geförderten Projekte zu ganz neuen Erkenntnissen geführt. Mit den Grants konnte der Hopfenspezialist der Wissenschaft immer wieder entscheidende Impulse geben.
Noch bis zum 31. Juli können sich Wissenschaftler und Wissenschaflterinnen auf den BarthHaas-Grant 2024 bewerben

Die Aufgaben stellte Robert Pawelczak, Staatliche Berufsschule Main-Spessart
Fachfragen und Fachrechnen für Auszubildende
Insbesondere beim Einatz von Mehrwegflaschen kommt der Reinigung eine entscheidende Bedeutung zu. Dazu durchläuft das Leergut in der Flaschenwaschmaschine mehrere Spritz-, Weichund Laugestationen. Neben der Reinigung müssen auch Etiketten und Folien entfernt werden.

1. Welche Faktoren beeinflussen den Sinnerschen Kreis?
a) Anfangskeimzahl, Chemie, Mechanik, Zeit
b) Anfangskeimzahl, Mechanik, Temperatur, Zeit
c) Chemie, Kontaminationsart, Temperatur, Zeit
d) Chemie, Mechanik, Temperatur, Zeit
e) Kontaminationsart, Mechanik, Temperatur, Zeit
2. Was kann die Inspektionstechnik in einer Flaschenfüllerei nicht leisten?
a) Kontrolle der Stammwürze
b) Kontrolle des Etikettensitzes
c) Kontrolle der Flaschenform
d) Füllhöhenkontrolle
e) Restflüssigkeitskontrolle
3. Welches Bauteil gehört nicht zum Etikettierungsaggregat?

a) Palettenkarrussel
b) Leimwalze
c) Greiferzylinder
d) Eitkettenmagazin
e) Anbürststrecke
4. Die Flaschenreinigungsmaschine verlassen viele Flaschen, an denen Etiketten anhaften. Was ist die wahrscheinlichste Ursache für diesen Fehler?
a) Vorweiche zu kalt
b) Spritzdüsen der Heißwasserzone verstopft
c) Etikettenaustragsbehälter ist überfüllt
d) Laugekonzentration ist zu hoch
e) Druck der Frischwasserspritzung ist zu niedrig
5. Wie viele Flaschen müssen nach dem Eichgesetz für die Kontrolle der Füllhöhe bei der Abfüllung am Füller entnommen werden?
a) Immer 100 Flaschen
b) Nennleistung der Füllerei/1000
c) 1 Flasche pro Organ
d) Ein beliebiger kompletter Bierkasten
e) Die Flaschenzahl zweier Füllerumläufe
6. Wodurch entstehen in der Flaschenreinigungsmaschine „angelaufene“ Flaschen?
a) Zu schnelle Laufleistung der Anlage
b) Zu niedrige Laugetemperatur
c) Zu hohe Temperatur im Warmwasserbecken
d) Zu hohe Wasserstoffperoxiddosage im Kaltwasserbecken
e) Zu hohe Laugekonzentration
7. Für die Abfüllung welchen Getränks wäre bei der Flaschenreinigung die niedrigste Laugekonzentration erforderlich?
a) AfB
b) AfG
c) Bier
d) Mineralwasser
e) Saft
8. Welche Aufgaben erfüllen Tenside im Rahmen der Flaschenreinigung?
a) Sie senken die Oberflächenspannung der Reinigungsmedien
b) Sie haben eine glanzverbessernde Wirkung für Glasflaschen
c) Sie verhindern Scuffing
d) Sie haben eine desinfizierende Wirkung
e) Sie verstärken die Lösung anorganischer Anhaftungen
Eine Abfülllinie hat einen Nenndurchsatz von 50 000 Flaschen pro Stunde. Die Flaschenreinigungsmaschine soll einen Durchsatz von 120 % des Flaschenfüllers erreichen. Die Effektivdurchsatz der Anlage liegt bei 90 %. Wie viel Wasser benötigt die Hochdruckeinspritzung (HDE), die pro Flasche einen halben Milliliter einspritzt, mit den gegebenen Bedingungen während einer 8 Stunden-Schicht? (ganze L)
ELEKTROMOBILITÄT
Die Berliner-Kindl-Schultheiss-Brauerei kommt bei der Umrüstung auf alternative, klimaschonende
Antriebe voran: Jetzt schickt die Hauptstadtbrauerei ihre ersten batterieelektrischen Lkw auf die Straße, um die weitere Dekarbonisierung der Logistik voranzutreiben.
(F.) Die E-Lkw übernehmen Vollund Leergut-Transporte von Berlin über Potsdam bis in das südliche Mecklenburg-Vorpommern. Bei den Fahrzeugen des Typs Volvo FM Electric handelt es sich um Zweiachser Sattelzugmaschinen mit einem zulässigen Gesamtgewicht von 44 t und bis zu 300 km Reichweite. Die Leistung des alternativen Antriebs entspricht dem eines 500 PS Dieselfahrzeugs. „Mit den ELkw loten wir aus, inwieweit sie sich in unserem Fuhrpark bewähren und ihre Praxistauglichkeit im Logistikalltag dauerhaft beweisen. Verläuft der Test erfolgreich, plant unsere Unternehmensgruppe die
Anschaffung weiterer schwerer Lastkraftwagen“, so Uwe Sofke, Leiter Logistik der Berliner-KindlSchultheiss-Brauerei.
Im Rahmen des Pilotprojekts werden die E-Lkw eine Jahreslaufleistung von jeweils 60 000 km erbringen. Datengetriebene Erkenntnisse werden Routen optimieren, Ladepläne automatisieren, Transportkosten minimieren und natürlich Emissionen reduzieren. Allein bei ihrem Einsatz auf der Strecke von Berlin nach Potsdam sparen die beiden E-Lkw schätzungsweise 140 t CO2 pro Jahr gegenüber den bisher auf genutzen Dieselfahrzeugen. Vorteile bringt ihr Einsatz nicht
nur für die Umwelt. Auch die Fahrer profitieren: Die batteriegetriebenen Nutzfahrzeuge sind deutlich leiser als Lkw, die von fossilen Brennstoffen angetrieben werden. Die Fahrerkabine heizt sich im Sommer nicht durch Motorabwärme auf und verschmierte Hände nach dem Tanken gehören ebenfalls der Vergangenheit an. Mit dem Ausbau des E-Fuhrparks samt hochmoderner E-Ladeinfrastruktur setzt die Berliner-KindlSchultheiss-Brauerei ein „grünes“ Signal an ihrem Heimatstandort. Schon in ihrer innerbetrieblichen Logistik haben sich E-Gabelstapler bewährt.

Die BerlinerKindl-SchultheissBrauerei hat den Probebetrieb mit E-Lkws des Typs Volvo FM Electric gestartet
Hauptsponsoren:
Die 108. brau- und maschinentechnische Arbeitstagung der VLB Berlin, gemeinhin bekannt als VLBFrühjahrstagung, fand vom 13. bis 15. März 2024 im nordholländischen Groningen statt. Darüber, dass Ressourcenknappheit und Klimawandel uns alle vor immer gewaltigere Herausforderungen stellen, herrscht Einigkeit: „Klimaneutralität ist keine Option mehr, sie ist ein Muss.“ Entsprechend lautete das Motto der beiden Vortragstage „Brewing industry is moving towards net zero“. Und wie sich herausstellen sollte, hat jedes Unternehmen seine ganz eigene Strategie, die Netto-Null zu erreichen.

(ew) Nachdem am Mittwoch, 13. März, die Fachausschüsse der VLB Berlin getagt und die Teilnehmer sich im Anschluss bei einem gemütlichen Get-together im Tagungszentrum MartiniPlaza bereits ausgetauscht hatten, standen am Donnerstag die ersten Vorträge auf dem Programm. Souverän und mit sehr viel Humor führte Jens Hoffmann (Warsteiner Braugruppe) durch einen abwechslungsreichen Tag, an dem Wissenschaft und Praxis gleichermaßen

Prof. Dr. Frank Behrendt (TU Berlin):
Moderne Technologien müssen effizient und flexibel sein – dabei spielen Speichersysteme eine wichtige Rolle
zu Wort kamen und ihre Perspektiven auf bzw. Lösungsansätze für die Herausforderungen unserer Zeit präsentierten. In Anlehnung an das Rahmenprogramm, nämlich Holland Malts Eröffnung der ersten emissionsfreien Mälzerei der Welt, standen die Vorträge unter der Frage, wie kann die Brauindustrie das Netto-Null-Ziel erreichen? Das sei das richtige Thema am richtigen Ort, so Hoffmanns einführende Worte.
Den Anfang machte Prof. Dr. Frank Behrendt (TU Berlin). Mit seinem Vortrag Energy supply as a challenge – fossil and renewable sources gewährte er einen Einblick in die aktuelle Situation und schilderte die Entwicklung hinsichtlich der Energieversorgung mit fossilen und erneuerbaren Quellen. In Deutschland wurden 2022 rund 18 % des gesamten Primärenergiebedarfs durch erneuerbare Energie gedeckt. Allerdings entfallen auf Gas und Öl nach wie vor rund 60 %. Die Umwandlung von regenerativ erzeugtem Strom, allen voran Wind und Photovoltaik, in andere Energieträger (Gas, Flüssig, Wärme) erfordert neue, effiziente und gleichzeitig flexible Technologien. Um die Schwankungen zwischen einer dezentralen Erzeugung und dem Verbrauch auszugleichen, kommen Speichersystemen eine Schlüsselrolle zu. Die Transformation darf sich allerdings nicht ausschließlich auf Energieerzeugung

Jens Hoffmann (Warsteiner) moderierte den ersten Vortragstag
und Speicherung richten. Vielmehr muss die Industrie zunächst erhebliche Mengen an Energie einsparen. Ziel von Forschung und Entwicklung ist es, die schwankenden regenerativen Energieströme auszubalancieren und die Maßnahmen so zu gestalten, dass der Energiebedarf gleichmäßig verteilt und Spitzen möglichst vermieden werden.
Jan-Maarten Geertman und Jeroen Schrijvers (Heineken) erklärten, wie Heineken seine Net-Zero-

Heineken verfolgt einen ambitionierten Zeitplan, seine Netto-Null-Ziele zu erreichen. Wie das gelingen soll, erläuterten Jeroen Schrijvers (l.) und Jan-Maarten
Geertman
Emissionsziele erreichen möchte. Der Zeitplan ist ambitioniert: Scope 1 (direkte Emissionen) und Scope 2 (indirekte Emissionen der Energielieferanten) sollen in allen 160 Produktionsstätten in 70 Ländern bis 2030 auf Null gesenkt werden. Beim Scope 3 (indirekte Emissionen der vor- und nachgelagerten Lieferketten) strebt man bis 2040 die Netto-Null an. Im Brauprozess liegen die größten Einsparungspotenziale bei Heizung und Kühlung. Gelingt es, um bis zu 20 % des Verbrauchs einzusparen, würde dies pro Standort zu einer CO2Reduzierung von bis zu 50 %
führen. So sollen Wärmepumpen, die mit erneuerbarer Energie betrieben werden, die Wärme- und Kälteerzeugung elektrifizieren. Ein Beispiel: In Sevilla betreibt Heineken seit 2023 eine solarthermische Anlage, die größte in Europa. Sie soll 60 % der fossilen Brennstoffe ersetzen und ca. 7000 t CO2 pro Jahr einsparen.
Doch Heineken nimmt auch die Zulieferindustrie in die Verantwortung und arbeitet gemeinsam mit Logistik- und Verpackungslieferanten am Netto-Null-Vorhaben. So wird beispielsweise der flächendeckende Einsatz von E-Trucks getestet. Auch die Land -

Dr. Brigitte Skadhauge und Michael Jakob schilderten ihre innovativen Strategien, Carlsbergs CO 2 -Fußabdruck Richtung Null zu reduzieren
wirtschaftsbetriebe werden angehalten, weniger Düngemittel einzusetzen und Gerste bzw. Hopfen nachhaltig anzubauen.
Heineken holt die Zulieferer mit ins Boot. Carlsberg geht da einen anderen Weg. Welchen, das erklärten Dr. Brigitte Skadhauge (Carlsberg Research) und Michael Jakob (Carlsberg New Technologies) in ihrem Vortrag Brauerei 4.0 – Wie Carlsberg die Brauindustrie evolutioniert . Die Strategie der dänischen Brauereigruppe in puncto nachhaltige Optimierung der Produktionsprozesse ist umfassend. Man ist dabei, einige traditionelle Verfahren über Bord zu werfen. Dabei setzt man auf verschiedene neue Schlüsseltechnologien. Der Konzern strebt eine regenerative Landwirtschaft an unter Einsatz von optimierten Getreidesorten. Außerdem setzt man auf „digitale Zwillinge“, die die Produktionsprozesse simulieren und hinsichtlich ihrer Ressourcenverbräuche optimieren. Darüber hinaus soll die Herstellungszeit des Bieres von 12 auf 4,5 Tage reduziert werden, und zwar mit einem neu entwickelten Gärverfahren. Das Gärverfahren wurde bei Kronenbourg in Frankreich, bei der Hue Brewery in Vietnam und in Foshan, China, bereits erfolgreich angewendet. Ein weiterer Meilenstein ist das DryHopping-Verfahren CaviHop. Die in der Kavitationszone erzeugten Schockwellen ermöglichen eine nahezu sofortige Extraktion der Hopfenöle. Dabei kann bis zu 20 % mehr Aroma aus aus den Pflanzen herausgeholt werden als gängigen Aromahopfensorten. Ein weiterer Baustein ist das sog. „Late manufacturing“, bei dem aus Standardbieren erst kurz vor der Abfüllung die speziellen Sorten ausgemischt werden.
Die Zielvorgaben bei Carlsberg sind ambitioniert: Bis 2030 sollen die Brauereien emissionsfrei produzieren, bis 2040 soll die gesamte Wertschöpfungskette CO2neutral werden. Dabei sollen alle von Carlsberg entwickelten Innovationen auch für Dritte verfügbar gemacht werden.
Wie aus Grolsch eine klimaneutrale Brauerei wurde, erzählte Susan Ladrak mit einer außergewöhnlichen Erfolgsstory. Hoch
weitere Sponsoren:
Susan Ladrak schilderte, wie Grolsch zusammen mit dem niederländischen Abfallwirtschaftsbetrieb Twence die Klimaneutralität erreichen will

motiviert zeigten sich die knapp 700 Mitarbeiter der niederländischen Brauerei, die erste klimaneutrale Produktionsstätte der Welt zu werden. Mit ins Boot holte man sich im Frühjahr 2020 den Abfallwirtschaftsbetrieb Twence, der sich auf die Fahne geschrieben hat, vom Abfallverwerter zum Hersteller von Rohstoffen und Energie zu werden. Twence liefert nachhaltige Energie (u.a. aus Altholz) in Form von Warmwasser. Diese Wärme wiederum nutzt die Brauerei aus Enschede, um bspw. den Pasteur, die Flaschenwaschanlagen

oder das Gebäude zu beheizen. 2022 wurden dafür im Übrigen eine zusätzliche Versorgungsleitung unterhalb der Autobahn verlegt. Im Juli dieses Jahres soll außerdem ein Windpark ans Netz gehen, der Grolsch mit weiterer erneuerbarer Energie absichert.
Die bisher erreichten Energie-Einsparungen können sich sehen lassen: 5,6 t CO2 und 3,1 Mio. Nm3 Erdgas, berichtete die Projektleiterin durchaus mit Stolz.
Nach dem Vortragsprogramm folgte der feierliche Höhepunkt der VLBFrühjahrstagung: Holland Malt eröffnete die weltweit erste emissionsfreie Mälzerei, und zwar im 30 km entfernten Eemshaven an der Nordseeküste. Dort betreibt Holland Malt seit etwa 20 Jahren eine große Mälzerei mit vier Türmen und einer Produktionskapazität von jährlich rund 280 000 t Malz. Mit dem Ziel, die CO2-Emissionen bei der Malzherstellung drastisch zu reduzieren, wurde dort die gesamte Beheizung der Darren von Erdgas auf Wärmepumpen umgestellt. Installiert wurden zwei Wärmepumpen mit Leistungen von 22 MW und 4 MW
sowie ein entsprechend dimensionierter Wärmespeicher. Über eine mehrstufige Wärmerückgewinnung wird Heißwasser auf Temperaturniveaus von 67 °C und 95 °C in den Darren bereitgestellt. Die beiden Wärmepumpen werden mit „grünem“ Strom betrieben. Dabei spielt der Standort Eemshaven eine besondere Rolle: Der dortigen Nordseeküste ist ein großer Offshore-Windpark vorgelagert. Außerdem verläuft dort eine Haupttrasse für den Stromtransport von Norwegen und Dänemark in die Niederlande. Entsprechend hat man direkten Zugriff auf große Mengen Strom aus regenerativen Quellen.
Die Projektzeit von der Konzeption bis zur Inbetriebnahme betrug etwa drei Jahre. Die gesamte Umrüstung fand im laufenden Betrieb statt. Lediglich für den finalen Anschluss des Systems an die Malzproduktion war eine Produktionsunterbrechung von vier Wochen unvermeidbar.
Das Unternehmen scheute weder Kos ten noch Mühen und feierte mit mehr als 400 internationalen Gäs ten aus Industrie und Politik die Einweihung seiner klimaneutralen Mälzerei mit einer opulenten Party. Noch vor dem Festakt wurden die Besucher durch alle Bereiche der laufenden Mälzerei geführt.
Das Herzstück der emissionsfreien Anlage: eine der beiden Wärmepumpen, die den gesamten Mälzungsprozess mit Wärme versorgen (unten links) Im Keimkasten in einem der vier Mälzereitürme (unten rechts)

Der 25. VLB-Logistikfachkongress fand vom 4. bis 6. März in Chemnitz statt. Rund 160 Teilnehmer diskutierten
über Trends in der Digitalisierung, den KI-Einsatz und nachhaltige Prozessoptimierung in der Getränkelogistik.
Eine Besichtigung der Batterieproduktion der Triathlon Group in Glauchau rundete die Veranstaltung ab.
(oh) Der erste Vortagstag stand unter der Leitung von Michael Kappesser, Getränke Schneider. Der Tag wurde eröffnet von VLB-Geschäftsführer Dr. Josef Fontaine mit einem Rückblick auf 25 Jahre VLB-Logistikfachkongress. Erstmalig 1998 in Stuttgart durchgeführt, hat die Veranstaltung inzwischen einen festen Platz im Kalender zahlreicher Getränkelogistiker. IT-gesteuerte Lagerverwaltungssysteme, Einwegpfand, LKW-Maut, Mehrweglogistik, Flaschensortierung bis hin zum Einsatz künstlicher Intelligenz waren nur einige der Themen, die in den zurückliegenden Jahren diskutiert wurden. Dabei folgten in Summe mehr als 5200 Teilnehmer den 427 Fachvorträgen. „Wir sind stolz darauf, dass wir mit unserem Logistikfachkongress eine feste Kommunikationsplattform für die Getränkebranche etablieren konnten“, so Fontaines Fazit. Aus Anlass des Jubiläums wurde beim Get-together am Vorabend Michael Kröhl, Krombacher Brauerei, dafür geehrt, dass er bislang bei allen 25 VLB-Logistikfachkongressen dabei war. Weitere Stammbesucher waren Roland Keul (23x), Gerolsteiner Brunnen, sowie Michael Kappesser, Getränke Schneider, und Jörg Schulte, Schulte Bender und Partner (beide je 20x).

Trends bei Digitalisierung und KI Künstliche Intelligenz (KI) – die neue Generation , war Thema von Prof. Dr. Peter Buxman n von der Technischen Universität Darmstadt. Künstliche Intelligenz ist seit 1960 Gegenstand der wissenschaftlichen Diskussion. Es gab viele Prognosen hinsichtlich Einsatzbereichen und Zeiträumen, viele davon haben sich nicht erfüllt. Das Grundprinzip des maschinellen Lernens ist das Training der KI mit konkreten Datensätzen. Dabei nimmt die Präzision mit der Menge der Trainingsdaten zu. ChatGPT hat seit der Gründung im Jahre 2015 eine rasante Entwicklung erfahren. Man müsse sich aber im Klaren darüber sein, dass ChatGPT eine Blackbox ist. Niemand weiß genau, mit welchen Daten die KI trainiert worden ist und wie sie zu ihren Schlussfolgerungen kommt. Daher gibt es nach wie vor auch Risiken:

Beim sogenannten „Halluzinieren“ liefert die KI völlig falsche Ergebnisse, die allerdings auf den ersten Blick überzeugend dargestellt und begründet werden. Auch die Generierung von Fake-Videos oder Bildern ist ein Risiko, das große Auswirkungen auf gesellschaftliche und politische Prozesse haben kann.
Anwendungsmöglichkeiten von KI in der Wirtschaft liegen derzeit in den Bereichen der Wissensverwaltung, der Auswertung von Daten oder der Softwareentwicklung. Dort könne der Einsatz von ChatGPT Produktivitätssteigerungen von 3050 % ermöglichen. Um echte Produktivitätsfortschritte in einem Unternehmen zu erzielen, müsse die KI allerdings mit den spezifischen Daten und der Wissensbasis des Unternehmens trainiert werden. Diese Integration von KI in klassische IT-Strukturen stellt nach wie vor eine Herausforderung dar. Dennoch wird die Verbreitung von KI auch in Unternehmen weiter fortschreiten: „Die Welt wird nie mehr so langsam sein wie heute!“, so das Fazit von Prof. Buxmann.
Digitalisierung und KI im Wertschöpfungsnetzwerk der Getränkeindustrie – Ein Gedankenspiel war Thema von Christian Grad t, PRECOGIT GmbH. Bei der Betrachtung der gesamten Logistikkette von Lieferanten über Her-
Michael Kappesser (2.v.l.), Getränke Schneider, leitete den ersten Kongresstag
Der 25. VLB-Logistikfachkongress wurde unterstützt von


Die Tagung fand im Carlowitz Congresscenter Chemnitz statt
Die beiden weiteren Rednerpanels des ersten Tages

stellung bis zum Kunden gibt es immer wieder Brüche im Informationsfluss. Dennoch ist die Digitalisierung in vielen Bereichen inzwischen weit fortgeschritten und gilt als vierte industrielle Revolution. Beispiele für Einsatzbereiche sind u.a. die Verzahnung von Mensch und Maschine, z.B. durch Augmented Reality, KI, Exoskelette. In der Logistik kann KI Planungsprozesse durch Lieferantenqualifikation, Absatzprognosen oder Automatisierung von Bestellvorgängen unterstützen. Auch die automatische Lagerhaltung lässt sich optimieren. Weitere Chancen bieten sich in den Bereichen Markt- und Preisanalysen. Um im Markt künftig bestehen zu können sind offene Plattformen, standardisierte Daten, KI-unter-

stütze Automatisierung und Transparenz entscheidend. Aber: „Trotz aller KI – der Mensch bleibt,“ so das Fazit von Gradt.
Cloud4Log: der digitale Lieferschein in der Praxis , wurde von Stefanie Müller, GS1 Germany, und Steffen Riedel , Eckes-Granini Deutschland, präsentiert. In diesem Projekt haben sich unter Federführung von GS1 und der Bundesvereinigung Logistik (BVL) mehr als 20 Unternehmen zusammengeschlossen. Gemeinsames Ziel ist, eine Pilotlösung für einen standarisierten digitalen und cloudbasierten Lieferschein zu entwickeln und unter
realen Bedingungen zu erproben. Inzwischen setzen mehr als 100 Unternehmen das Cloud4Log-System ein, darunter Handelsketten wie dm, Aldi Süd, Penny, Rewe und andere. Der Datenaustausch erfolgt über eine Cloud, die von GS1 und der BVL betrieben wird. Zentraler Informationsträger sind QR-Codes, eine gesonderte App ist nicht erforderlich. Aktuell werden 12 Sprachen unterstützt. Über erste Erfahrungen bei der Umsetzung von Cloud4Log bei Eckes Granini berichtete Steffen Riedel. Der LKW-Fahrer scannt bei der Abholung den QR-Code und erhält damit alle Informationen zur Tour in seiner bevorzugten Sprache. Das sei gerade in der Transportlogistik mit häufig nichtdeutsch-sprechendem Personal eine echte Erleichterung, so Riedel. Insgesamt soll Cloud4Log mit wenig Aufwand sehr viel Nutzen bieten: „Ich kann ihnen wirklich keinerlei Nachteile dieses Systems nennen“, so Riedels Fazit. Der Zugang ist erst einmal kostenlos. Erst wenn richtige Transaktionen getätigt werden, entstehen Gebühren. Diese liegen aktuell bei 0,30 € jeweils für Versender, Transporteur und Empfänger.
Automatisierung
Jetzt mal Butter bei die Fische: Wie automatisiere ich meine Logistik? lautetet der Titel des Vortags von Florian Kratzer, Still GmbH. Auch wenn der Wunsch nach Automatisierung in der Intralogistik bei vielen Unternehmen sehr ausgeprägt ist, sieht es in der Realität teilweise noch recht bescheiden aus. Anspruch und Wirklichkeit driften mitunter deutlich auseinander, so Kratzert. Am Anfang der
Planung eines fahrerlosen Transportsystems erfolgt eine genaue Analyse der komplexen Prozesse. Im nächsten Schritt erfolgt die Auswahl der Technologien (Scanner, Kontrollleuchten, Sicherheitsmaßnahmen etc.). Dann erfolgt die Entscheidung, ob eine zentrale oder dezentrale Steuerung erforderlich ist. Natürlich sind Investitionen in Hard- und Software erforderlich. Dem gegenüber stehen Vorteile wie Zuverlässigkeit, Transparenz und die größere Unabhängigkeit vom Personal. Die Entwicklung einer passenden Individuallösung für den Kunden kann unter Umständen mehrere Monate in Anspruch nehmen. Als Praxisbeispiel stellte der Referent die Automatisierung des Lagers bei der Güldenkron Fruchtsaft GmbH, bei der Elsdorfer Molkerei und Feinkost und bei der Radeberger Gruppe vor. Dort konnten ROIs von unter drei Jahren erreicht werden.
Revolutionäre Integration: Automatisches Regallager optimiert die Intralogistikprozesse war der Vortrag von Thomas Bobe , Hassia Mineralquellen, und Daniel Beck, Kardexmlog Logistics. Hassia verfügt über einen großen automatisierten Logistikbereich. Täglich werden bis zu 6000 Paletten verladen. Unbefriedigend war bislang die Situation im Leerguthandling mit nicht optimaler Lagerung und hohem Personalaufwand. Im Herbst 2020 wurde dafür ein neues Regallager konzipiert, das hochautomatisiert an die bestehende Fördertechnik angebunden werden sollte. Ende 2022 ging das System in Betrieb. Realisiert wurde das Hochregallager mit 28 640 Stellplätzen für Europaletten mit Hochbau und Technik einschließlich der gesamten Anbindung an die Hassia-interne Elektrohängebahn von kardexmlog. Während der gesamten Bauphase
konnte die Produktion am Standort weitergeführt werden. Die Investitionen summierten sich auf rund 17 Mio. €. Insgesamt konnte damit das Handling des Leerguts weitgehend automatisiert, transparent und wesentlich effizienter gestaltet werden.
Über stauraum- und prozessoptimierte Paletten-Kommissionierung von Getränke-Gebinden mittels integriertem SoftwareModul berichteten Roland Freund , Cargoload, und Thorsten Weibel , Römerwall Naturbrunnen und Getränke. Der Römerwall Naturbrunnen gehört zur HövelmannGetränkegruppe. Ausgehend von einer wenig effizienten Kommissionierung wurde die Projektierung eines Hochregallagers beschlossen. Ziel war es, die Durchlaufzeiten zur optimieren, Transparenz in der Stellplatzverwaltung zu schaffen und den gesamten Prozess zu optimieren. Auf KI-Unterstützung wurde bewusst verzichtet. Eine Herausforderung bestand im sicheren Handling der kommissionierten Paletten bei unterschiedlichen Kastenformaten. Nach detaillierten Vorüberlegungen wurde für die Optimierung der Palettenbelegung ein Berechnungsmodul von Cargoload eingesetzt. Dieses errechnet für jede Palette eine dreidimensionale Optimierung der Packungen und Laderaumbelegung. Für gängige Säulenmuster wurden Standardbelegungen vorbereitet. Für stark durchmischte Palettenbeladungen liefert das Berechnungsmodul formschlüssige Ladungsmuster. Für die Umsetzung einschließlich der Einrichtung eines Picking-Tools der Firma syscron wurden zwei Jahre benötigt.
Ein IoT Device für ihren Batteriepool stellte Rafael Michel , Triathlon Batterien, vor. Eine Batterie darf nicht nur als reiner Energiespeicher gesehen werden, sondern kann auch ein intelligenter Teilnehmer im digitalen Datenaustausch sein. Vorteile einer Digitalisierung von Batterien sind u.a. erhöhte Effizienz, Kosteneinsparung, Wartungsoptimierung und optimale Lade-/ Entladeprozesse. Predictive Maintenance basiert auf der laufenden Datenanalyse von Maschinen und Anlagen. Ziel ist es, die Wahrscheinlichkeit künftiger Ausfallereignisse

Ehrung „alter Logistikfüchse“: VLB-Präsident Ulrich Rust (3.v.r.) und VLB-Geschäftsführer und Mit-Initiator des Logistikfachkongresses, Dr. Josef Fontaine (2.v.l), ehrten in Chemnitz ihre treuesten Teilnehmer: Michael Kröhl, Krombacher Brauerei (3.v.l.), der an allen 25 Kongressen teilgenommen hat, Wolfgang Maul (l.), ehem. Hassia-Gruppe, Michael Kappesser (2.v.r.), Getränke Schneider, und Roland Keul (r.), Gerolsteiner Brunnen – alle mit jeweils mehr als 20 Teilnahmen
vorauszuberechnen und damit zu minimieren. Das Tool TriConnect von Triathlon ermöglicht das Monitoring eines Batteriepools in Echtzeit. Darin können Status, Ladezustand , Spannung und Temperatur jeder Batterie angezeigt werden. Darüber hinaus können verschiedene statistische Auswertungen gefahren werden, die viele Ansätze für Optimierungen des Elektro-Fuhrparks liefern. Insgesamt sind damit die Batterien in den E-Fahrzeugen aktive Komponenten, die nicht nur Strom, sondern auch zahlreiche nützliche Daten zu Betriebszuständen und Nutzung liefern.

Bei Triathlon in Glauchau erhielten die Teilnehmer einen Einblick in die Produktion von Hochleistungsbatterien für industrielle Anwendungen
Besichtigung Batterieproduktion
Im Anschluss ging es für alle Teilnehmer in das benachbarte Glauchau zur Besichtigung des Werkes der Triathlon Batterien GmbH. Dort entwickelt und produziert das Unternehmen leistungsstarke Bleisäureund Lithiumionen-Batterien für den Einsatz in elektrisch betriebenen
Flurförderzeugen, Elektrohubwagen, mobilen Hubarbeitsbühnen oder Reinigungsmaschinen. Der Weltmarkt für die Fertigung einzelner Batteriezellen – sowohl Bleisäure als auch Lithiumionen – wird von Herstellern in China, Indien oder Korea dominiert In Glauchau werden dann importierte Einzelzellen je nach Einsatzzweck und Kunde endkonfektioniert. D.h. die Batteriezellen werden je nach gewünschter Leistung verdrahtet, mit einer Regelelektronik ausgestattet und in ein Gehäuse verbaut. Der Markt wächst aktuell sehr dynamisch, sodass Triathlon derzeit seine Produktionsstätten weiter ausbaut.
Prämierungen: www.craftspiritsberlin.de/awards/ ergebnisse-2024/
Craft Spirits Berlin Awards 2024 verliehen
Bei der Ehrung der Preisträgerinnen und Preisträger gab es am 2. März 2024 im Säälchen in Berlin ein Get-together von jungen Wilden und Traditionsbrennern.
(BF) Die Branche präsentierte erneut Ideenreichtum kombiniert mit feinstem Handwerk. Unter den Produkten fanden sich originelle Neuheiten wie ein Destillat aus Eicheln und eine Apfel-Zirben-Spirituose. Daneben gab es Klassiker wie Gin, Rum, Whisky, Wodka und Kräuterlikör. Gut 570 Spirituosen, Likörweine, Bottled Cocktails, alkoholfreie Spirituosenalternativen und Softdrinks bewertete die Jury. „Die Strahlkraft des Wettbewerbs zeigt sich an den Einsendungen aus aller Welt“, sagte Organisator Theo Ligthart. „Auch Brennereien aus Australien, Indien und Lateinamerika nutzen die Awards als Sprungbrett auf den internationalen Markt“. Mitveranstalter Dr. Thomas Kochan ergänzte: „Wir sind stolz, dass unser Siegel nach 13 Jahren so anerkannt ist. „Der Weg in die Bars, die Restaurants und den Handel wird durch eine Auszeichnung bei den Craft Spirits Berlin Awards

geebnet – das ist gerade für kleine Handwerksbetriebe ein Türöffner.“
Craft Spirit of the Year 2024 wurde am Ende der Bärlauchgeist der Hausbrennerei Fridolin Baumgartner. Craft Distillery of the Year 2024 in Gold wurde das VLB-Mitglied Birkenhof Brennerei, Silber erhielt die Säly Edelbrände aus Österreich und Bronze die Humbel Spezialitätenbrennerei aus der Schweiz. Die Birkenhof Brennerei wurde außerdem zu einer der World’s Best Craft Distilleries gekürt. Einzelauszeichnungen erhielt sie u.a. für ihre Brände aus Vogelbeeren, Wildorangen, Rote Bete bzw. Hefeweißbier. VLBPartner MXPSM machte mit seinem Adler Wodka das Rennen. Alle

Die 21-köpfige internationale Jury aus Sensorik-Expertinnen und Experten bewertete die Produkte anhand eines 100-Punkte-Schemas in Blindverkostungen nach Geruch, Geschmack, Balance und Typizität. Gestaffelt nach der erreichten Punktzahl werden Gold-, Silber- und Bronzemedaillen verliehen. Werner Albrecht, SpirituosenExperte des Bundesministeriums für Ernährung und Landwirtschaft, sprach ein Grußwort, in dem er besonders die handwerkliche Leistung der Kleinbetriebe würdigte.


16. bis 18. September 2024 im Eventhotel Pyramide in Vösendorf bei Wien
Die führende deutschsprachige Fachtagung für Brenner und Spirituosenhersteller

Mit Unterstützung von Aromen für Spirituosen und Liköre ... Obstbrennerei... Digitalisierung... Nachhaltigkeit... Spezialhefen für die Brennerei... Rahmenbedingungen... Spirituosenanalytik...



Am 15. April hat an der VLB Berlin der Kurs zum Bier- und Spirituosensommelier begonnen. Neun Kandidaten sind aus ganz Deutschland und der Schweiz angereist, um die Geheimnisse und den Zauber von Spirituosen und Bier zu studieren, neues Wissen zu erwerben und vorhandenes zu vertiefen. Beim Gastro-Partner der VLB, dem Michelberger Hotel im Szene-Bezirk Berlin-Friedrichshain, werden die Teilnehmer lernen, dieses Wissen Kunden in Gastronomie sowie Handel zu vermitteln und ebenso sinnvolle wie fantasiereiche Pairings von Bier mit Spirituose sowie mit Speisen zu kreieren.
dafür machen“, bringt es ein Gasthausbrauer auf den Punkt.
VLB-Geschäftsführer Dr. Josef Fontaine sagt zur Begrüßung: „Wir freuen uns sehr, dass wir diesen Kurs mit Ihnen starten können.“ Er beschreibt, wie im Jahr 2020 die Idee entstand, einen Sommelierkurs zu entwickeln, der Bier und Spirituosen vereint. VLB Berlin und IfGB bringen dabei ihre große Sensorik-Kompetenz, aber auch technisch-technologisches Wissen ein. Für den Bereich Bier und Spirituose in Gastronomie und Hotellerie sowie Food-Pairing konnten Tom und Nadine Michelberger, die neuen Eigentümer der Preussischen Spirituosen Manufaktur (nun MXPSM), mit ihrem Gastro-Team gewonnen werden.
Zwei kompakte Wochen mit Informationen und Tastings zu unter-
schiedlichsten Bier- und Spirituosenkategorien liegen am Tag der Begrüßung vor den Kursteilnehmern, aufgelockert mit technischen Exkursen und Besichtigungen von Brauereien und Spirituosenbetrieben. Der Gastro-Unterricht findet im Michelberger Hotel, der dazu gehörenden Farm sowie in der SzeneBar Ora in Berlin-Kreuzberg statt. Bereits beim Begrüßungsabend ist die Stimmung sehr gut und angeregte Fachplaudereien zwischen Teilnehmern und Veranstaltern sowie untereinander nehmen ihren Lauf. „Ich bin hier genau richtig!“, sagt ein Teilnehmer begeistert nach dem ersten Unterrichtstag. „Ich habe mir den Stundenplan angeschaut und bin beeindruckt, was Ihr alles für uns auf die Beine stellt“, ergänzt ein anderer.

Künftige Bier- und Spirituosensommeliers mit Kursleiter Christopher Bergtholdt, Koordinatorin Wiebke Künnemann und Dozent Timo Lützenberger (v. r. n. l.) Mit Unterstützung von (WiK) „Die Teilnehmer sind hoch motiviert, aber auch bereits bestens ausgebildet“, freut sich Kursleiter Christopher Bergtholdt. Bei den angehenden Sommeliers handelt es sich sowohl um Destillateure und Brenner als auch um Mitarbeiter von Gasthausbrauereien. Hinzu kommen Teilnehmer, die sich beruflich neu orientieren und erstmal per Kundenperspektive in das Metier einsteigen wollen. Ein Teilnehmer kommt von einer Supermarktkette, die zu unterschiedlichen Themen Tastings anbieten. Manche Teilnehmer haben bereits Erfahrung in der professionellen Vermittlung von Wissen über Bier oder Spirituosen und wollen nun die jeweils andere Kategorie besser verstehen. „Je mehr wir über ein Produkt wissen, desto besser können wir Marketing


Am 10. und 11. April trafen sich 20 Sensoriksachverständige der Deutschen Landwirtschafts-Gesellschaft (DLG) im Testzentrum Gau-Bickelheim, um rund 350 Spirituosen aller Kategorien zu verkosten. Die Sensorik, ergänzt um Analytikergebnisse und Deklarationsprüfung, ergeben die Grundlage für die DLG-Gold-, Silber- oder Bronzemedaille.


(WiK) Thomas Burkhardt, Projektleiter Getränke der DLG, begrüßte die Verkoster aus Forschungs- und Lehrinstituten, von Verbänden, aus Brennereien, von Spirituosenherstellern sowie aus Unternehmen der Zulieferindustrie. „Ich freue mich sehr darüber, dass wir wieder zusammen sind.“ Burkhardt erklärte, dass es inzwischen drei Prüftermine pro Jahr gibt. „Wir sind sehr glücklich über diese drei Termine“, sagte später ein Hersteller. „Heutzutage fordern die Handelspartner umgehend eine Qualitätsbewertung, damit sie unsere Produkte listen. Da können wir dann nicht ein Jahr auf den nächsten DLG-Test warten.“
Der Projektleiter Getränke betonte: „Der erste Termin im Jahr ist weiter der Haupttermin mit der größten Probenzahl.“ Lisa Weyerhäuser, DLG, hat mit ihrem Team die Veranstaltung vorbereitet. Christopher Bergtholdt, VLB Berlin, ist der verantwortliche Prüfbevollmächtigte. Die ergänzende Spirituosenanalytik und Deklarationsprüfung erledigt das Analytikteam der VLB Berlin. Die Verkoster nahmen in ihren nach Kategorien eingeteilten Teams Platz. Manche verkosten bereits seit Jahrzehnten miteinander, andere arbeiteten das erste Mal zusammen. Nach einer kurzen Abgleichsverko -
stung im gesamten Panel startete jedes vierköpfige Verkosterteam mit seinen Spirituosen. Gespannte Ruhe herrschte im Raum, während die Sensorikexperten die Proben nach Farbe, Klarheit, Geruch und Geschmack bewerteten. Dann begann ein leiser Singsang: „5, 5, 4, 4; 5,5, 4, 3; 5,5,5,5,5“, meldeten die Verkoster ihre Bewertungen, den Schriftführern. Es folgten weitere Zahlencodes als Begründung einer Abwertung: „2010, 3938, 1005...“ Gibt es einen Range-Fall (mind. ein Verkoster bewertet 2 Punkte schlechter oder besser als die übrigen) herrscht Gesprächsbedarf. Dann wird diskutiert und argumentiert, bis man ein weitgehend einheitliches Bild erreicht. Gelingt es einem Team nicht, das Problem zu lösen, kommt der Prüfbevollmächtigte dazu, verkos tet, bewertet und nimmt Stellung. Als letzte Instanz kann er das Produkt von einem weiteren Team erneut verkosten lassen. Solche Streitfälle sind extrem selten. So freuten sich Christopher Bergtholdt und Thomas Burkhardt über eine große Übereinstimmung und Harmonie. Die Gesamtergebnisse werden Mitte Mai erwartet. Anmeldeschluss für Proben der weiteren Spirituosentests sind 27.5. und 9.8.2024

Am 10. April verabschiedete die Deutsche Landwirtschafts-Gesellschaft (DLG) Ralf Hapke im Rahmen des Verkoster abends 2024 in Gau-Bickelheim in den Verkos terruhestand. Der ehem. Technische Leiter der August Ernst GmbH & Co. KG war 30 Jahre lang für die DLG aktiv.
(BF) Der Geehrte war nicht nur als Sensoriksachverständiger, sondern seit 1998 auch als Vorsitzender der DLG Kommission Spirituosen tätig. „Für diesen Einsatz wurden Sie im Jahr 2016 mit der DLG-Max-EythDenkmünze geehrt“, erinnerte DLG-Projektleiter Getränke Thomas Burkhardt. „Wir sind sehr froh über Ihre engagierte Unterstützung.“ Mit Blick auf die unterschiedlichen Austragungsorte der Spirituosenverkostung sagte der Projektleiter
Getränke: „Bad Kreuznach, Oppenheim, Groß-Umstadt, Karlsruhe, Frankfurt, Heilbronn, Köln oder Gau-Bickelheim – immer waren Sie zur Stelle.“ Burkhardt bedauerte sehr, dass für Hapke nun die letzte DLG-Prüfung anstand.
Ralf Hapke bedankte sich für die Ehrung und erinnerte an die lange gemeinsame Zeit mit den Sensoriksachverständigen der DLG, mit denen er nun noch einmal zusammen sitzen und fachsimpeln konnte: „Wichtig ist mir immer der interdisziplinäre Austausch gewesen. Es ist mir eine Ehre, in diesem Jahr noch einmal an der Spirituosenverkostung der DLG teilnehmen zu dürfen.“
Die DLG muss sich von verdienten Sensoriksachverständigen trennen, wenn diese in den Ruhestand treten und damit nicht mehr regelmäßig im Betrieb an Sensoriktests teilnehmen.
Ralf Hapke war nicht nur langjähriger Spirituosenverkoster, sondern bekleidete weitere Ehrenämter wie den Vorsitz des BSI-Ausschusses für Berufsausbildung und Nachwuchsförderung. Als Vorsitzender
Am 10. April ehrte die Deutsche Landwirtschafts-Gesellschaft (DLG)
Richard Nusser, Leiter Qualitätssicherung der Rola Weinbrennerei + Likörfabrik, mit der Max-Eyth-Denkmünze in Bronze für sein langjähriges Engagement als DLG-Sensoriksachverständiger für Spirituosen.
(BF) Die Laudatio hielt Thomas Burkhardt, DLG-Projektleiter
Getränke: „Die DLG-Prüfung für
Spirituosen unterstützen Sie schon lange in vielfältiger Art und Weise. Als wissenschaftlicher Mitarbeiter

Der DLG-Prüfbevollmächtigte für Spirituosen Christopher Bergtholdt (l.), VLB, überreicht die Max-Eyth-Denkmünze an Dr. Richard Nusser

Thomas Burkhardt (l.) überreicht Ralf Hapke Hausaufgaben für den Ruhestand: deutsche Weine testen!
des IHK-Prüfungsausschusses für Destillateurmeister brachte er, nach der Insolvenz der VLSF im Jahr 2002, den Destillateurmeisterkurs an die VLB Berlin.
des damaligen Prüfbevollmächtigten Prof. Dr. Klaus Misselhorn im Jahr 2001 und in den Jahren 2002 und 2003 als sein Nachfolger in der Prüfbevollmächtigten-Position der DLG-Spirituosenprüfung. Sie sind seit 2005 Mitglied in der DLG-Kommission Spirituosen. Außerdem waren Sie schon über 20 Mal als Sensoriksachverständiger für Spirituosen im Einsatz.
Diese besondere Einsatzbereitschaft und Leistung möchten wir heute entsprechend würdigen. Wir dürfen Ihnen im Namen der DLG dafür herzlich danken und für die besonderen Verdienste um die Facharbeit in der DLG und die Förderung der Deutschen Land- und Ernährungswirtschaft die Max-Eyth-Denkmünze in Bronze überreichen“, sagte Burkhardt.
Dr. Nusser hat nach der Insolvenz der VLSF 2002 die Spirituosenanalytik an der VLB aufgebaut. Außerdem war er langjähriger Dozent in den Destillateurkursen des IfGB und Mitglied der IHKPrüfungskommission für Destillateurmeister.

Die deutschen Börsen sind fest in das Jahr 2024 gestartet. Bis zum Februar-Ultimo legte der Dax 40 (FAZ-Index) +5,5 (+3,9) % zu auf 17 678 (2581) Punkte, womit der Dax 40 seinen bisherigen Rekord übertraf.
Die Umlaufrendite der Bundesanleihen lag am 29. Februar 2024 bei durchschnittlich 2,54 %, die Inflationsrate im Euro-Raum bei 2,80 %, und für 1 € gab es 1,083 US-$.
ABI: 4. Quartal 2023 Im Konzern von Welt-Bierprimus Anheuser-Busch InBev stellte sich der Getränkeabsatz im 4. Quartal 2023 (2022) um -4,1 Mio. hl auf 144,7 (148,8) Mio. hl. Im laufenden Geschäft wurden -3,9 Mio. hl weniger verkauft (-2,6 %), hinzu kamen -0,15 Mio. hl aus Konzernveränderungen in Nordamerika. Der Rückgang kam vom Eigenbier, von dem 123,8 (128,5) Mio. hl verkauft wurden (vergleichbar -4,6 Mio. hl bzw. -3,6 %), während sonstige Getränke +3,0 % zugewannen. Auf der Ebene Getränkeabsatz brach Nordamerika ein auf 19,7 (23,5) Mio. hl (vergleichbar -3,6 Mio. hl bzw. -15,3 %): Der US-Großhändlerabsatz (STW) brach -16,1 % (nach -8,6 %) ein, auch wegen „Bud Light“, und Kanada verlor hoch einstellig. Schwächer zeigte sich Asien/Pazifik auf 15,5 (15,9) Mio. hl (-2,8 %): China gab -3,1 % ab (wobei Premium und SuperPremium zweistellig zulegten) und Südkorea mittel einstellig. Europa/ Nahost/Afrika schloss leichter auf 24,0 (24,1) Mio. hl (vergleichbar -0,2 Mio. hl bzw. -0,7 %): Europa gab klein einstellig ab und Nigeria-Bier hoch einstellig, während Südafrika klein einstellig mehr verkaufte. Südamerika behauptete sich knapp bei 46,7 (46,9) Mio. hl (-0,3 %): Brasilien tendierte +0,8 % freundlicher (Bier: -1,1 %), während Argentinien mittel einstellig abgab. Freundlicher zeigte sich nur Mittelamerika um +0,3 Mio. hl auf 38,6 (38,3) Mio. hl (+0,9 %): Kolumbien legte mittel einstellig zu, Mexiko und Peru gaben klein einstellig ab und Ekuador mittel einstellig. Der Konzernumsatz von IFRS-Bilanziererin ABI stellte sich im 4. Quartal 2023 auf netto 14,5 (14,7) Mrd. US-$. Vergleichbar er-
löste Leuven +0,9 Mrd. US-$ mehr (+6,2 %; Umsatz/hl +9,3 %), aus der Argentinien-Hyperinflation kamen +1,2 Mrd. US-$, Konzernveränderungen standen für -0,1 Mrd. US-$ und die Währungsumrechnung verzehrte -2,2 Mrd. US-$ (allein Südamerika: -2,5 Mrd. US-$).
In Nordamerika stellte sich der Nettoumsatz auf 3,3 (3,9) Mrd. US-$.
Umsatzrekord 2023
Heute in der Brau-BörsenBilanz
• AB InBev
Im Gesamtjahr 2023 (2022) hat der ABIKonzern damit 584,7 (595,1) Mio. hl Getränke verkauft (vergleichbar -10,3 Mio. hl gleich -1,7 %), davon 505,9 (518,0) Mio. hl Eigenbier (vergleichbar -12,0 Mio. hl gleich -2,3 %); sonstige Getränke tendierten +2,1 % freundlich. Beim Getränkeabsatz standen Nordamerika für -12,5 Mio. hl (USGroßhändlerabsatz: -12,7 %), Südamerika für -1,9 Mio. hl und Europa/ Nahost/Afrika vergleichbar für -0,8 Mio. hl (bei Südafrika-Absatzrekord), während Mittelamerika +1,1 Mio. hl und Asien/Pazifik +3,8 Mio. hl mehr verkauften. Beim Nettoumsatz wurde ein Rekord auf 59,4 (57,8) Mrd. US-$ herausgestellt: Vergleichbar erlöste Leuven +4,5 Mrd. US-$ mehr (+7,8 %, Umsatz/hl +9,9 %; Nordamerika: -1,4 Mrd. US-$), aus Konzernveränderungen kamen -0,1 Mrd. US-$, und die Wechselkurse verzehrten -2,7 Mrd. US-$. (2023 wertete 1 € durchschnittlich 1,08 US-$ und zum Jahresultimo 1,105 US-$.) Die Umsatzkosten stiegen +4,1 % auf 27,4 (26,3) Mrd. US-$ (vergleichbar +9 %). Der Betriebsgewinn stellte sich auf 14,6 (14,8) Mrd. US-$ (Nordamerika: -1,3 Mrd. US-$ durch die Umsatzlücke). Einmaleffekte saldierten sich auf -0,6 (-0,3) Mrd. US-$ Aufwand (2023 mit -0,3 Mrd. US-$ Aufwand aus dem Verkauf von US-Getränkemarken). Das Finanzergebnis verbesserte sich auf -4,8 (-5,0) Mrd. US-$ Aufwandssaldo, es
• Carlsberg
• Heineken u. a.
enthielt -3,1 (-3,3) Mrd. US-$ Nettozinskosten. Nach -2,2 (-1,9) Mrd. US-$ Ertragsteuern schloss ABI im Konzern mit 6,89 (7,60) Mrd. US-$ Jahresüberschuss, von denen 5,34 (5,97) Mrd. US-$ den Aktionären der Muttergesellschaft zuzurechnen waren. Leuven sprach von einem weiteren Jahr mit beständigem profitablem Wachstum. Direkt im Eigenkapital gebucht wurden +3,88 (-1,32) Mrd. US-$ Mehrung (2022: Minderung) überwiegend aus der Bilanzumrechnung von Fremdwährungstöchtern. Die ABI-Konzernbilanz längte sich zum Ultimo 2023 (2022) auf 219 (213) Mrd. US-$. Auf der Vermögensseite waren vor allem mehr Goodwill und immaterielle Werte zu sehen und im Umlaufvermögen, zu beiden Stichtagen konstant, weniger Vorräte, dafür mehr Forderungen sowie Kasse. Auf der Finanzierungsseite gingen die langfristigen Verbindlichkeiten etwas stärker zurück als die kurzfristigen stiegen, das Eigenkapital erhöhte sich auf 92,7 (84,3) Mrd. US-$ (EK-Quote 42,3 nach 39,6 %). Netto cash in Sachen und immaterielle Werte investiert hat ABI 2023 (2022) -4,5 (-4,8) Mrd. US-$. Für 2024 erwartete Leuven zum Februarultimo einen Zuwachs beim Betriebsgewinn vor Abschreibungen (EBITDA) von 4-8 % (heuer ohne Umsatzprognose) und 4-4,5 Mrd. US-$ Invest. Am 19. Dezember 2023 meldete ABI die Übernahme ihres minderheitlichen Anteils an der AB InBev Efes BV durch Anadolu Efes. Der Vollzug werde ohne Zahlung erfolgen.
Heineken: Absatzminus in Q4 Im Heineken-Konzern stellte sich der Getränkeabsatz im 4. Quartal 2023 um -2,2 Mio. hl auf 68,4 (70,6) Mio. hl. Im laufenden Geschäft wurden -2,2 Mio. hl (-3,2 %) weniger verkauft,
Konzernveränderungen standen saldiert für +0,1 Mio. hl. Dabei gab Bier ab auf 59,4 nach 63,3 Mio. hl (-2,1 Mio. hl vergleichbar, -1,9 Mio. hl aus Konzernveränderungen). Sonstige Getränke schlossen bei 6,8 nach 5,5 Mio. hl (-0,2 Mio. hl vergleichbar, +1,4 Mio. hl aus Konzernveränderungen). Und Handelsgetränke von Dritten stiegen auf 2,2 (1,7) Mio. hl durch Konzernveränderungen (+0,6 Mio. hl). Ihren Gruppenbierabsatz einschließlich 3,6 (3,3) Mio. hl Lizenzbier bei Dritten und Absatzanteilen bei Minderheitsbeteiligungen nannte Amsterdam mit 70,7 (75,0) Mio. hl. Bei den Getränken kam der stärkste Absatzrückgang aus der Region Asien/Pazifik mit -1,3 Mio. hl auf 11,2 Mio. hl (-10,1 %, von Bier). Europa verlor auf 19,9 (21,2) Mio. hl (-0,9 Mio. hl gleich -4,0 % vergleichbar, -0,4 Mio. hl aus Konzernveränderungen, vor allem Verkauf von AfGTochter Vrumona am Heimatmarkt). Afrika/Nahost/Osteuropa tendierte im laufenden Geschäft -0,2 Mio. hl leichter (-1,4 %), verkaufte aber 12,9 nach 12,5 Mio. hl dank saldiert +0,5 Mio. hl aus Konzernveränderungen (Afrika-Verstärkung gegen Russland-Aufgabe). Allein Amerika zeigte sich mit +0,1 Mio. hl auf 24,3 Mio. hl gut behauptet (+0,2 %, von Bier). Die Marke „Heineken“ legte +4,0 % zu auf 15,4 Mio. hl mit Plus in Asien/Pazifik und Amerika. Seinen Umsatz konnte der nach IFRS bilanzierende Familienkonzern im
Bier ist eine große, profitable und wachsende Kategorie, die weltweit Anteile am Markt für alkoholische Getränke gewinnt und beträchtlichen Raum für Premium-Ausbau bietet.
Aus der ABI-Pressemitteilung zum 4. Quartal und Gesamtjahr 2023
4. Quartal 2023 hingegen ausweiten auf netto 7,78 (7,42) Mrd. €. Im laufenden Geschäft wurden +0,35 Mrd. € mehr erlöst (+4,8 %), aus Konzernveränderungen kamen +0,38 Mrd. €, die Währungsumrechnung verzehrte -0,38 Mrd. €.
Absatzminus & Umsatzplus 2023 Im Gesamtjahr 2023 hat der Heineken-Konzern damit 275,8 (288,4) Mio. hl Getränke abgesetzt (-13,6 Mio. hl gleich -4,7 % vergleichbar, +1,0 Mio. hl als Saldo der Konzernveränderungen). Dabei stand Bier für 242,6 (256,9) Mio. hl (-12,0 Mio. hl gleich -4,7 % vergleichbar, zu mehr als 60 % aus Vietnam und Nigeria; -2,4 Mio. hl aus Konzernveränderungen). „Heineken“ gewann +2,5 % auf 56,3 Mio. hl. „Amstel“ verkaufte hoch einstellig mehr, „Moretti“ klein einstellig, während „Desperados“ mittel einstellig verlor. Sonstige Getränke gaben vergleichbar -1,3 Mio. hl ab, stiegen aber durch +2,7 Mio. hl
AB InBev: Die Geschäftsjahre 2023 und 2022 im Vergleich
1 US-$ = 0,952 €
aus Konzernveränderungen auf 25,0 (23,6) Mio. hl. Die Zider (inkl. Zukäufen 7,1 Mio. hl) gaben im laufenden Geschäft ab. Handelsgetränke von Dritten stellten sich auf 8,2 (7,9) Mio. hl (vergleichbar -0,3 Mio. hl). Der Gruppenbierabsatz wurde mit 288,6 (301,4) Mio. hl angegeben, er enthielt 13,1 nach 11,1 Mio. hl Lizenzbier bei Dritten. Zurück zum Getränkeabsatz, wo Asien/Pazifik einbrach auf 43,9 (49,0) Mio. hl (-10,4 %) und Europa verlor auf 92,1 (98,1) Mio. hl (vergleichbar -5,4 Mio. hl gleich -5,5 %, -0,5 Mio. hl aus Konzernveränderungen). In Europa sei der HoGa-Bereich besser gelaufen als der Handel. Afrika/Nahost/Osteuropa gab ab auf 49,4 (50,8) Mio. hl (vergleichbar -2,8 Mio. hl gleich -5,6 %, +1,5 Mio. hl aus Konzernveränderungen). Auch im Gesamtjahr behauptete sich Amerika am besten mit -0,2 Mio. hl gleich -0,2 % auf 90,4 (90,6) Mio. hl.
Der Konzernumsatz konnte 2023 netto +5,7 % ausgeweitet werden auf 30,4 (28,7) Mrd. €. Im laufenden Geschäft wurden +1,6 Mrd. € mehr erlöst (+5,5 %, hl-Umsatz +10,8 %), Konzernveränderungen trugen per Saldo +0,9 Mrd. € bei und die Wechselkurse zehrten -0,9 Mrd. € auf. Der Materialaufwand stieg überproportional +7,8 % auf 20,1 (18,6) Mrd. €. Das Betriebsergebnis stellte sich auf 3,2 (4,3) Mrd. €. Es wurde belastet durch -0,7 Mrd. € nicht zahlungswirksame Wertberichtigungen
Quelle: AB-InBev-Pressemitteilung zum 4. Quartal und Gesamtjahr 2023 (Basis: IFRS-Konzernabschluss). US-$/hl und EBIT-Rendite: S.W. US-$/hl für Nordamerika und in Summe verzerrt durch Nichtgetränke-Umsätze. EBIT = Gewinn vor Finanzergebnis und Ertragsteuern; normalisiert = ohne Einmaleffekte (außerordentliche Erträge/Aufwendungen)

(davon -0,5 Mrd. € auf Heineken Beverages mit dem Geschäft im südlichen Afrika) und -0,2 Mrd. € durch die Umgliederung des negativen Unterschiedsbetrags aus der RusslandWährungsumrechnung aus dem Eigenkapital in die Erfolgsrechnung nach Abgabe des Russlandgeschäfts (BF10-2023, S. 22). Das Finanzergebnis stellte sich auf -0,9 (-0,3) Mrd. € Aufwandssaldo. Nach konstant 0,2 Mrd. € Beteiligungsertrag und nur -0,1 (-1,1) Mrd. € Ertragsteuern dank Einmal-Entlastung (+0,8 Mrd. €, vor allem aus Brasilien) schloss Amsterdam 2023 mit 2,40 (3,04) Mrd. € Jahresüberschuss, von dem 2,30 (2,68) Mrd. € den Aktionären der Mutter zuzurechnen waren. Der Vorschlag für die Gesamtdividende 2023 lautet auf erneut 1,73 €/Aktie. Direkt im Eigenkapital gebucht wurden -0,46 (+0,30) Mrd. € Minderung (Vorjahr: Mehrung) aus der Bilanzumrechnung von Fremdwährungstöchtern und aus Sicherungsgeschäften. Die Heineken-Konzernbilanz längte sich zum Ultimo 2023 (2022) auf 55 (52) Mrd. €. Auf der Vermögensseite standen vor allem mehr Sachanlagen und Vorräte. Auf der Finanzierungsseite stiegen die Finanzverbindlichkeiten sowie das Eigenkapital (dieses auf 22,8 nach 21,9 Mrd. €, Quote 41,3 nach 41,8 % durch die Bilanzverlängerung). Die betrieblichen Investitionen wurden netto cash ausgeweitet auf -2,7 (-2,1) Mrd. €, auch für BrasilienKapazitätsausbau. Für 2024 erwartete Amsterdam Mitte Februar in einem schwankungsanfälligen geopolitischen und wirtschaftlichen Umfeld ein Plus beim vergleichbaren Betriebsgewinn vor Einmaleffekten und Markenabschreibungen im breiten Band zwischen einem klein und einem hoch einstelligen Prozentsatz. Dabei ging Heineken von überdurchschnittlichen Lohnerhöhungen 2024 aus. Die Investitionen in Sachen und immaterielle Werte wurden brutto mit unter 9 % vom Nettoumsatz prognostiziert (2023: 8,8 %).
Carlsberg: Absatz in Q4 2023 gut Im Carlsberg-Konzern tendierte der Bierabsatz im 4. Quartal 2023 freundlicher auf 19,6 (19,4) Mio. hl. Das Mehrvolumen kam aus Asien mit 6,8 (6,4) Mio. hl. Westeuropa zeigte sich stabil bei 6,6 Mio. hl, Mittel- und Osteuropa leichter auf 6,2 (6,4) Mio. hl. Der Absatz sonstiger Getränke
stellte sich auf 5,7 (5,8) Mio. hl, unter kleinem Plus in Westeuropa auf 3,7 (3,6) Mio. hl. Insgesamt zeigten sich die Getränkeverkäufe am Elefantentor damit gut behauptet. Umgesetzt hat der Konzern von IFRS-Bilanziererin Carlsberg daraus netto 15,5 (14,6) Mrd. DKK (+6,3 %) mit Zuwachs vornehmlich in Westeuropa (8,8 nach 8,1 Mrd. DKK). (1 € stand für 7,45 Dänenkronen.)
Russland-Entkonsolidierung
Im Gesamtjahr 2023 konnte der Carlsberg-Konzern seine Getränkeverkäufe so mit 125,1 (125,4) Mio. hl knapp behaupten (-0,3 %, davon -0,5-%punkte vergleichbar und +0,2-%punkte aus Konzernveränderungen). Für Stabilität sorgte Asien mit +3,7 % Mehrabsatz auf 50,0 (48,3) Mio. hl: Vietnam legte in einem einbrechenden Markt hoch einstellig zu, hoch einstellig im Plus auch Indien, Laos und Kambodscha-Bier, während China-Bier +5 % zugewann. Westeuropa stellte sich -2,3 % auf 43,4 (44,4) Mio. hl: Frankreich und Polen gaben mittel einstellig ab, Großbritannien und die Schweiz klein einstellig, und Skandinavien zeigte sich stabil dank AfG. Mittel- und Osteuropa gab -3,2 % ab auf 31,7 (32,7) Mio. hl (vergleichbar -4,0 %punkte): Italien brach nach Preiserhöhungen zweistellig ein, die baltischen Staaten gaben mittel einstellig ab, Kasachstan und Weißrussland klein einstellig, stabil zeigte sich die Ukraine, und im laufenden Geschäft mehr verkauften Griechenland und Serbien. Bier stand konzernweit für konstant 101,0 Mio. hl (-0,1 %, davon -0,4 %punkte vergleichbar). „Tuborg“ gewann +3 %, „Carlsberg“ lag stabil. Das Premium-Segment habe +1 % freundlicher tendiert, Konsumbier schwächte sich -2 % ab. Alkoholfreie Biere machten +3 % gut. Sonstige Getränke tendierten -0,9 % leichter auf 24,1 (24,4) Mio. hl. „Somersby“Zider gab -6 % ab. Der Konzernumsatz stieg 2023 netto +4,7 % auf 73,6 (70,3) Mrd. DKK. Im laufenden Geschäft wurden +9,2 %punkte mehr erlöst (hlUmsatz +10 % mit Zuwachs in allen Regionen), Zukäufe steuerten +0,6 %punkte bei und die Wechselkurse verzehrten -5,1 %punkt. Die Umsatzkosten stiegen überproportional +6,7 % auf 40,8 (38,2) Mrd. DKK (Umsatzkosten/hl vergleichbar +11 %). Der Betriebsgewinn vor Einmal-
effekten stellte sich auf 11,1 (11,5) Mrd. DKK. Einmaleffekte saldierten sich auf -0,4 (-0,8) Mrd. DKK Aufwand (2023 mit -0,5 Mrd. DKK Wertberichtigungen auf Marken). Das Finanzergebnis stellte sich auf -0,8 (-0,7) Mrd. DKK Aufwandssaldo. Nach -1,9 (-1,8) Mrd. DKK Ertragsteuern schloss das fortgeführte Kopenhagen-Geschäft mit 7,97 (8,18) Mrd. DKK. Die Entkonsolidierung des Russland-Geschäfts im Juli 2023 führte zu einem Verlust aus nicht fortgeführtem Geschäft in Höhe von -47,75 (-8,1) Mrd. DKK. Er enthielt insgesamt -41,5 Mrd. DKK aus der Umgliederung des negativen Unterschiedsbetrags aus der Währungsumrechnung (-40,9 Mrd. DKK) und der Marktbewertung von Finanzinstrumenten (ca. -0,5 Mrd. DKK) mit Russland-Bezug aus dem Eigenkapital (vgl. BF 10-2023, S. 22), weiter die nach dem Kontrollverlust erfolgte Ausbuchung des verbliebenen Russland-Wertansatzes von 7,0 Mrd. DKK, sowie +0,76 Mrd. DKK Halbjahresgewinn. Damit schloss der Carlsberg-Konzern mit -39,8 (+0,1) Mrd. DKK Fehlbetrag (2022: Überschuss), von dem -40,8 (-1,1) Mrd. DKK den Aktionären der Mutter zuzurechnen waren und +1,0 (+1,2) Mrd. DKK den Minderheiten. Als sonstiges Ergebnis direkt im Eigenkapital gebucht wurden +38,6 (-4,1) Mrd. DKK Mehrung (Vorjahr: Minderung), fast komplett aus der Bilanzumrechnung von Fremdwährungstöchtern, und damit 2023 aus der vorgenannten Umgliederung der historisch aufgelaufenen Eigenkapitalschmälerungen wegen Russland in die Erfolgsrechnung: Diese Umgliederung erhöht zunächst das Eigenkapital, das anschließend über den Jahresverlust aus der Erfolgsrechnung wieder belastet wird, nun aber auf einer anderen Unterposition: als abschließende Minderung der Rücklagen. Der Carlsberg-Dividendenvorschlag für 2023 lautet erneut auf 27 DKK/Aktie. Die Carlsberg-Konzernbilanz kürzte sich zum Ultimo 2023 (2022) auf 112 (115) Mrd. DKK. Auf der Vermögensseite wurden 12 Mrd. DKK RusslandVermögen ausgebucht, gegenläufig stiegen vor allem Kasse und Wertpapiere des Umlaufvermögens um zusammen +7,5 Mrd. DKK. Auf der Finanzierungsseite wurden 4 Mrd. DKK Russland-Verbindlichkeiten ausgebucht, die Finanzverbindlichkeiten stiegen um +10,5 Mrd. DKK, und das Eigenkapital stellte sich -9,0
Mrd. DKK auf 25,7 Mrd. DKK (EK-Quote 23,0 nach 30,1 %). Die Belastung der Erfolgsrechnung durch -41,5 Mrd. DKK negative Eigenkapitalbestandteile mit Russland-Bezug war für das Eigenkapital wegen des gegenläufigen sonstigen Ergebnisses wie dargestellt netto neutral. Der Betriebsinvest stieg am Elefantentor 2023 (2022) netto cash auf -4,1 (-3,5) Mrd. DKK.
Kopenhagen schärft Ziele Für 2024 erwartete Kopenhagen Anfang Februar eine Steigerung beim vergleichbaren Betriebsgewinn um 1-5 %. Investiert werden sollen heuer ca. 5 Mrd. DKK auch in Asien-Kapazitätserweiterung. Unter dem neuen CEO Jacob Aarup-Andersen wurden die Ziele geschärft: Langfristig will Carlsberg sein Premium-Wachstum ausbauen, bei Angeboten jenseits von Bier und beim Asien-Wachstum schneller werden, profitables Wachstum in den Stamm-Märkten fördern (genannt wurden Skandinavien, die Schweiz, Frankreich und Laos), und die digitale Transformation vorantreiben. Beschrieben wurden auch Voraussetzungen bei Unternehmenskultur und Wirtschaftlichkeit. Der vergleichbare Umsatz soll künftig um durchschnittlich 4-6 % pro Jahr zulegen (zuvor lag die Messlatte bei 3-5 %), und der vergleichbare Betriebsgewinn noch stärker. Höherer Vertriebs- und Marketingaufwand soll finanziert werden auch aus einer wieder verbesserten Bruttomarge als Verhältnis „(Umsatz minus Umsatzkosten)/Umsatz“. 2019 berechnete sich die Bruttomarge mit 49,5 %, 2023 mit 44,6 % vom Umsatz. Und der Invest solle weiter bei ca. 6-7 % vom Umsatz liegen. Ab 2024 berichtet Kopenhagen zudem in neuem regionalem Zuschnitt: Die Region Asien gibt Indien und Nepal an die neue Region Mittel- und Osteuropa und Indien ab. Zudem übernimmt Westeuropa die Verantwortung für die zentralen Konzern-Dienstleistungen in Polen, die bisher keiner Region zugeordnet waren. Lübz bringt neu ein „Lübzer Küsten Hell“ (4,9 % vol.)
S.W.
Konzernabschlüsse 2023 im Überblick
Geschäftsjahr 2023 (31.12.) AB InBev Heineken Carlsberg Molson Coors
MCBC-Einmaleffekte mit -161 Mio. US-$ (-149 Mio. €) Markenwert-Berichtigung auf „Staropramen“
VBE Jahresdurchschnitt
(MCBC: Jahresende, Carlsberg: fortgeführtes Geschäft)
Mio. hl
Konsolidierter Getränkeabsatz
Radeberger Pilsner, eine der bekanntesten deutschen Biermarken, startete im März 2024 eine Marktoffensive und einen veränderten Markenauftritt. Ein neues Markenlogo und eine frische Kommunikationskampagne sollen die Marke zeitgemäß fortführen.

(F.) Das klarer gestaltete Bauch etikett setzt das Markenlogo in Szene. Das auf Etiketten wie Kronkorken stärker betonte Stadtwappen der Bierstadt
Radeberg unterstreicht den Stolz der Marke auf ihre Herkunft. Der neu gestaltete Flaschenhals, bei dem künftig auf eine Über-KopfFolierung aus Aluminium verzichtet und auf ebenso wertige, aber umweltfreundlichere Papieretiketten gesetzt wird, frischen den Markenaufritt auf, ohne auf bewährte Gestaltungselemente zu verzichten. Olaf Plaumann, Geschäftsführer der Radeberger Exportbierbrauerei, sagt: „Mit diesen Veränderungen schafft unsere Marke eine perfekte Symbiose aus Tradition und Moderne, schreibt unsere stolze Geschichte konsequent fort und
bleibt auch nach diesen Veränderungen unverkennbar: ein Radeberger.“ Doch nicht nur in Handel und Gastronomie wird Radeberger mit seinem neuen Auftritt sichtbar, sondern auch mit einer Kommunikationskampagne aus Bewegtbild und Plakat. Marketingleiter Marco Domogalski erklärt: „Die Bilder, die wir in unserer neuen Kommunikation zeigen, fangen unsere neue Markenbotschaft ein: Mach, was Dir wichtig erscheint, was Dir persönlich Sinn stiftet und Dir Erfüllung gibt. Tue dies aus vollem Herzen und mit voller Leidenschaft. Dann wird das Leben zum Genuss.“
C. & A. Veltins
Frischer Geschmack, neuer Sortenimpuls: Veltins Helles Lager frischt im Frühsommer das Produktportfolio mit einem mild-süffigen Bier auf – mit einem neuen Auftritt in der grünen Veltins-Markenfarbe.
(F.) „Weil der Biermarkt im Wandel ist und die Menschen immer probierfreudiger werden, geben wir eine Antwort auf die neuen Geschmackswünsche – ein junges Bier soll eben vor allem erfrischend sein“, sagt Dr. Volker Kuhl, Geschäftsführer Marketing/Vertrieb der Brauerei C. & A. Veltins.
Während das klassische Helle in Deutschland gerade eine Wachstumsstory hinter sich hat, sind Lagerbiere mit internationalem Gebinde-Look und Geschmacksprofil bei weltoffenen Verbrauchern längst auf der Überholspur.
„Das neue Veltins Helles Lager gilt als klares Marken-Statement für unsere neue Bier-Generation. Mit traditionellem Absender und trend-
gerechter Präsentation in unseren Hausfarben trägt es die eindeutige Veltins-Marken-DNA“, so Kuhl. Die genussfreudige Veltins-Zielgruppe wünscht sich Modernität und Leichtigkeit, möchte aber zugleich alle Tugenden eines guten Bieres bewahrt wissen. Veltins Helles Lager ist mit seinem Refreshing-Charakter und dem mild-süffigen Geschmack gerade bei 5-Grad-Kühltemperatur die zeitgerechte Antwort auf diesen Verbraucherwunsch. Die dezente Hopfennote ohne Bittere wirkt differenzierend zum Veltins Pilsener. Der Alkoholgehalt der neuen Sorte bewegt sich mit 5,0 Vol. % zwischen Pilsener und Hellem. „Wir wissen um die Stimmigkeit eines ProduktMarken-Konzeptes, denn der perfekte Geschmack allein genügt nicht, sondern auch der Auftritt muss die Biertypik unterstützen“, ist Dr. Volker Kuhl überzeugt. Auch der Produktauftritt
ist ein Aufbruchssignal hin zum internationalen Markt. Die grüne Mehrwegflasche sorgt für einen starken Auftritt im Getränkeregal und steht zusätzlich im visuellen Selbstverständnis der internationalen Lagerbiere, was auch durch die Gebindegröße von 0,275 l Inhalt bei einer gleichzeitig leichten Glasflasche deutlich wird. Mit einer flankierenden Markenkampagne auf den klassischen Kommunikationskanälen sowie auf Social Media wird die Produkteinführung 2024/25 begleitet.

Hertha BSC und AB InBev Deutschland haben eine Partnerschaft über fünf Jahre vereinbart. Mit Beginn der Saison 2024/25 wird die bekannte Brauereigruppe offizieller und exklusiver Bierpartner der Herthaner.
(F.) Im Olympiastadion kommen Fans künftig in den Genuss von Beck’s Pils, Corona und Spaten Hell. „Wir sind sehr glücklich, dass wir einen so starken Partner in der Hertha-Familie begrüßen dürfen. Unsere Fans dürfen sich auf viele tolle Aktionen und Highlights freuen“, sagt HerthaGeschäftsführer Thomas Herrich.
„Wir möchten Hertha BSC langfristig und vertrauensvoll als Partner zur Seite stehen. Daher war auch uns diese Vertragslaufzeit ein besonderes Anliegen“, betont Fried-Heye Allers, Unternehmenssprecher von AB InBev Deutschland, und ergänzt: „Berlin und die Hertha stehen für Weltoffenheit und Vielfalt. Es sind
Eigenschaften, die hervorragend zu unseren Biermarken passen. Wir sind gefragt und etabliert in der Club- und Kneipenszene, aber auch im Späti an der Ecke. Mit der neuen Partnerschaft möchten wir im und rund ums Olympiastadion unseren Teil dazu beitragen, dass der Besuch für die Fans zu einem gelungenen Erlebnis wird.“
Fans im Olympiastadion dürfen sich nicht nur über das vielfältige, alkoholhaltige und alkoholfreie Angebot freuen, bei dem für jeden Geschmack etwas dabei ist. Außerdem besticht die Brauereigruppe mit Innovationen – denn AB InBev gilt im Bereich Event und Service als erfahren. Neue Schnellzapfanlagen verringern die Wartezeit für die Stadionbesucher auch bei hohem Andrang. Wer sich sein Bier selbst zapfen möchte, kann das an eigens dafür vorgesehenen Zapfanlagen tun. Vor den Toren des Stadions laden Hertha und sein neuer Partner
Foto:

die Fans vor und nach dem Spiel in einem Biergarten zum Verweilen ein.
Thorben Jeß, Vice President Team der Sportmarketingagentur Hertha BSC Sportfive, ergänzt: „AB InBevs Hingabe zur Qualität und Vielfalt sowie ihre Nachhaltigkeitsbestrebungen spiegeln die Werte von Hertha BSC wider und wir sind überzeugt, dass die Zusammenarbeit die Fanerfahrung bei unseren Spielen deutlich verbessern wird.“
Für jeden Geschmack etwas dabei: Ab der kommenden Saison heißt Herthas neuer Bierpartner AB InBev


Spaten Brauerei
„Seit 130 Jahren offiziell, wir brauten’s erste Münchner Hell“

1894 braut Spaten als erste Münchner Brauerei ein helles Bier, zunächst nach Pilsener Art. Ein Jahr später folgte dann das Münchner Hell. Mittlerweile nimmt dieser Klassiker eine wichtige Rolle im breitgefächerten Portfolio von AB InBev ein.
(F.) 1894 ist das neue Bier allein für den Versand nach Norddeutsch -
land bestimmt. Ein Jahr später bringt Spaten als erste Münchner Brauerei das Helle Bier in der bayerischen Metropole auf den Markt. Eine Premiere mit Vorbildcharakter. Andere Brauereien ziehen nach – und das in einer Zeit, in der in München und anderen Regionen Deutschlands ausschließlich dunkles süß-malziges Bier getrunken wird.
Spaten wächst mit den Jahren. 1909 lockt der Ruf Amerikas: Spaten wird für den regelmäßigen Export über den großen Teich verschifft. 1924 kommt der Slogan „Lass dir raten, trinke Spaten!“ heraus – eine Empfehlung, der viele folgen und die noch heute Gültigkeit hat. Spaten bleibt sich treu und aus Tradition innovativ. Seit dem vergangenen Jahr ist das leichte Premiumbier zusätzlich zur 0,5-Liter-Flasche auch im hand -
lichen 0,33-Liter-Format im Sixpack erhältlich. Auch Helles in der Halbliter-Getränkedose wird mehr und mehr angenommen und kann deutlich zulegen. Populär ist auch eine andere Variante: Perfect Draft – das praktische Mehrweg-6-LiterFass für die Party daheim. Heute ist Spaten mit seinem milden Geschmack eine der am schnellsten wachsenden Marken beim Hellen und ist damit nicht nur in München und Bayern zu Hause. In ganz Deutschland hat das Bier seine Fans, auch in weiten Teilen Westeuropas, in den USA, Japan und Neuseeland.
Auch die alkoholfreien Angebote boomen. Ein wichtiges Etappenziel möchte AB InBev 2025 erreichen: Bis dahin soll jedes fünfte Bier aus dem weltweiten Sortiment alkoholfrei oder zumindest alkoholreduziert sein.
Die Haus Cramer Gruppe setzt mit dem Neudesign ihres Oberbräu Hell auf eine moderne Interpretation der bayerischen Braukunst. Rechtzeitig zur Hellbiersaison weicht die Getränkegruppe den Fokus auf Brauchtum und Heimat etwas auf und bewegt sich in die Bildwelt moderner Leichtigkeit – zentrales Designelement: eine Gämse.
(F.) „Die ‚Gams‘ als zentrales Designelement symbolisiert Aufbruch und Abenteuer und soll eine junge Zielgruppe ansprechen, die Wert auf Biergenuss in lockerer und ungezwungener Atmosphäre mit Freunden legt“, erklärt Andreas von Grabowiecki, Marketing Direktor der Haus Cramer Gruppe. Den gelernten Color-Codes der Hell-Marken-Welt bleibt das neue Design mit dem modernen Dreh von beige, hell- und dunkelblau treu. Über den zeitgemäßen, aufgeräumten Look in
Kombination mit gelernten Codings möchte sich die Marke Oberbräu vom typisch bayerischen Wettbewerb abheben und platziert sich zugleich optimal im Hellbiermarkt. Gleiches gilt auch für seine über 400 Jahre alte Brautradition. „An der Rezeptur unseres mild-süffigen Hellen haben wir nichts verändert. Aus diesem Grund haben wir uns auch beim neuen Design bewusst für den Hinweis auf den Brauprozess ‚nach alter Tradition‘ auf dem Bauchetikett entschieden“, erklärt von Grabowiecki. „Uns ist es wichtig herauszustellen, dass wir kein neues Produkt einführen, sondern unser beliebtes Oberbräu Hell zeitgemäß weiterentwickeln, um aus der Masse der Hellbiere hervorzustechen.“ Das neue Outfit ist eine Investition mit Zukunft, denn die Kategorie der Hellbiere hat sich in den vergangenen Jahren als zweitstärkste Sorte auf dem deutschen Biermarkt etabliert.
Erhältlich ist das Oberbräu Hell im neuen Design für den Handel ab sofort u.a. in der 0,5-Liter-Euroflasche im 20-x-0,5-Liter-Kasten sowie im 6-x-0,5-Liter-Open-Basket. Gastronomiekunden erhalten das mildsüffige Helle für ihre Gäste zudem im 30- und 50-Liter-Fass. Im Zuge der Einführung des Neudesigns werden auch Werbematerialien und Ausstattungen für Handel und Gastronomie Schritt für Schritt umgestellt.

Brauring – Kooperationsgesellschaft Privater Brauereien
In Zusammenarbeit mit der VLB Berlin konnte Brauring den teilnehmenden Brauereien Anfang März einmal mehr ein buntes Seminar-Programm anbieten.
(F.) Nach der Begrüßung von Brauring-Geschäftsführer Matthias Hajenski und Jan Biering (VLB Berlin) überreichte Bernd Heitmann (Schwerter Brauerei, Meißen) dem Brauring-Geschäftsführer, der zum Jahresende in Ruhestand geht, eine Auswahl von Bierspezialiäten der teilnehmenden Brauereien und bedankte sich für die jahrelange vertrauensvolle Zusammenarbeit. Der erste Beitrag befasste sich mit der Braumeister-Ausbildung an der VLB und sprach den mittlerweile herrschenden Fachkräfte-Mangel an. Der darauffolgende Beitrag von Jan Biering behandelte die optimierte Wuchsstoffversorgung nach dem deutschen Reinheitsgebot. Danach berichtete Dr. Horst Born (Prominent) von der sicheren
Gesellschaft für Hopfenforschung (GfH)
Jahreshauptversammlung:
Zum Start ins neue Hopfenjahr lud die Gesellschaft für Hopfenforschung e.V. (GfH) zur Mitgliederversammlung ins Deutsche Hopfenmuseum nach Wolnzach ein.
(F.) Gemäß den Vereinsstatuten des weltweit über 450 Mitglieder starken Vereins gab Vorstandsvorsitzender Dr. Michael Möller den Rechenschaftsbericht über das abgelaufene Jahr ab und gleichzeitig einen Ausblick auf aktuelle Herausforderungen und Forschungsprojekte für die kommende Anbausaison.
In enger Kooperation mit der Bayerischen Landesanstalt für Landwirtschaft (LfL) wird am Hopfenforschungszentrum in Hüll praxisnah geforscht und an der Zukunftssicherung des Hopfenbaustandorts Deutschland gearbeitet. Zur Mitgliederversammlung referierten
Anwendung von Desinfektionsverfahren in Abhängigkeit von der Rohwasserqualität. Es folgten Erfahrungsberichte, u.a. aus der mikrobiologischen Betriebsberatung seitens der VLB.
Nach der Mittagspause setze Markus Köll (Dr. Küke) mit dem Vortrag „Chlordioxid mal anders“ die Vortragsreihe fort. Anschließend folgte die Verkostung der mitgebrachten Bierspezialitäten, bevor die Gruppe zum Besuch der Herbsthäuser Brauerei aufbrach. Dort präsentierten Inhaber Klaus Wunderlich und Braumeister Markus Lutz ihre hochmoderne Brauerei. Der gesellige Erfahrungsaustausch bei Abendessen und Bier beendete den ersten Seminartag.
Der zweite Tag begann mit den Exponaten der Teilnehmer der Zulieferindustrie. Maximilian Rempt (Leybold) referierte über die effiziente Vakuumtechnik für eine nachhaltige Bierabfüllung. Stefan Pfister und Korbinian von Terzi (Banke GmbH)
informierten über das Energiemanagement der Zukunft bzw. über moderne Sudhaustechnologien. Philipp Zeuschner (VLB Berlin) referierte über das IGF-Forschungsprojekt „BrewFlex – Elektrische Lastflexibilisierung und Effizienzsteigerung in der Brauerei“ und Jan Biering sprach über „Aktuelle Trends und Neuentwicklungen“. In der Abschlussdiskussion wurden dann auch die Themen für das nächste Seminar gesammelt.
Wie gewohnt im Taubertal: Teilnehmer und Referenten des Brauring-Seminars 2024

die Wissenschaftler insbesondere zu den Forschungsprojekten, die sich um die stetige Verbesserung der Nachhaltigkeit im Hopfenanbau bemühen. Dabei ging es um die sinnvolle Verwertung der Restpflanze nach der Ernte zu Pflanzenfasern und daraus hergestellten Dämmmatten; außerdem um die Förderung der Artenvielfalt im Hopfengarten. Darüber hinaus behandelten die Vorträge die Reduktion von chemisch-synthetischem Pflanzenschutz durch Nützlingseinsatz oder die Senkung des CO 2 -Footprints durch Neuzüchtungen. Alle aktuellen Forschungsergebnisse wurden im druckfrisch vorliegenden „Jahresbericht – Sonderkultur Hopfen“ veröffentlicht und den Mitgliedern ausgehändigt.

Gruppenbild vor Dolde: Der GfH-Vorstand nimmt die Hopfenkönigin in seine Mitte
Vereinigung ehem. VLBer e.V. – Brewers of Berlin
Die Vereinigung ehem. VLBer e.V. – Brewers of Berlin (Vereinigung ehem. Studierender am Institut für Gärungsgewerbe und Biotechnologie zu Berlin) lädt hiermit zur ordentlichen Mitgliederversammlung im 73. Jahr ihres Bestehens ein.
Die Mitgliederversammlung 2024 findet am Freitag, den 5. Juli 2024, um 15.00 Uhr, im Vorfeld des VLB-Sommerfests, im Raum Schultheiss (E.32) an der Versuchs- und Lehranstalt für Brauerei in Berlin e.V., Seestraße 13, 13353 Berlin, statt.
Tagesordnung
1. Eröffnung durch den 1. Vorsitzenden, Klaus Niemsch
2. Genehmigung des Protokolls der Mitgliederversammlung vom 7. Juli 2023
3. Tätigkeitsbericht des 2. Vorsitzenden, Jan Biering
4. Bericht des Kassenwarts
5. Bericht der Kassenprüfer
6. Aussprache
7. Entlastung des Vorstands
8. Wahl der Kassenprüfer
9. Diskussion und Abstimmung über eine Änderung der Mitgliedsbeiträge: Die beiden Vorsitzenden schlagen eine „Lifetime Fee“
vor. Als einmaliger Beitrag für eine lebenslange Mitgliedschaft werden 200 € vorgeschlagen. Begründung: Mit dieser Einmalzahlung ließ sich insbesondere die Verwaltung der internationalen Mitglieder vereinfachen. Gemäß Vereinssatzung Abschnitt „IV. Rechte und Pflichten der Mitglieder“, §9, ist die Mitgliederversammlung zu einer Änderung der Mitgliedsbeiträge berechtigt.
10. Beschlussfassung über eingegangene Anträge 11. Verschiedenes
Berlin, im April 2024
Klaus Niemsch Jan Biering (1. Vorsitzender) (2. geschäftsführender Vorsitzender)
Kontakt und Anträge (bis 21.6.2024): ehemvlber@vlb-berlin.org
Informationen und Anmeldung: www.vlb-berlin.org/ehemvlber

Freitag, 5. Juli 2024, Berlin

Die Vereinigung ehem. VLBer – Brewers of Berlin und die VLB Berlin laden am Freitag, dem 5. Juli 2024, von 16.00 bis 24.00 Uhr (letzter Einlass 22.00 Uhr) zum beliebten Sommerfest auf dem Hof und auf der Dachterrasse unseres Instituts an der Seestraße 13 in Berlin-Wedding ein. ### Voranmeldung erforderlich! ### https://www.vlb-berlin.org/sommerfest2024


Karriere bei der Versuchs- und Lehranstalt für Brauerei in Berlin (VLB) e.V.
Aktuelle Stellenangebote:
Laborant (w/m/d) im Bereich Mikrobiologie
Mitarbeiter (w/m/d) im Bereich Veranstaltungsorganisation
Werkstudent (w/m/d) im Forschungsinstitut für Management und Getränkelogistik & Veranstaltungsorganisation
Weitere Informationen und Bewerbung auf vlb-berlin.onapply.de
Fachfragen
1. d) / 2. a) / 3. e) / 4. c) / 5. c) / 6. e) / 7. d) / 8. a)
Fachrechnen
Die HDE ist Bestandteil des Füllers, der Nenndurchsatz der Flaschenreinigungsmaschine spielt daher bei dieser Berechnung keine Rolle:
Berechnung des effektiven Stundendurchsatzes am Füller: 100 % = 50 000 Flaschen/h 90 % = x Flaschen
x = 50 000 ∗ 90 100 = 45 000 Flaschen pro Stunde
Tagesnenndurchsatz am Füller:
45 000 Fl/h ∗ 8 h = 360 000 abgefüllte Flaschen pro 8-h-Schicht
Wasserverbrauch der HDE:
360 000 Fl ∗ 0,5 ml/Fl = 180 000 ml = 180 l pro Tag
Fachzeitschrift für Brauereien, Mälzereien, Getränkeindustrie und deren Partner
Informationsservice der VLB Berlin
ISSN 0179–2466
Herausgeber
Versuchs- und Lehranstalt für Brauerei in Berlin (VLB) e.V. Seestraße 13, 13353 Berlin
Redaktionsanschrift
Brauerei Forum
Seestraße 13, D-13353 Berlin
Telefon: (030) 4 50 80-251
Telefax: (030) 4 50 80-210
E-Mail: redaktion@brauerei-forum.de Internet: www.brauerei-forum.de
Redaktion
Olaf Hendel (oh) (verantwortlich) hendel@vlb-berlin.org
Eva Wiesgrill (ew), e.wiesgrill@vlb-berlin.org
Julia Bork (jb), j.bork@vlb-berlin.org
IfGB Aktuell: Wiebke Künnemann (WiK) kuennemann@vlb-berlin.org
Redaktionsbeirat
Dr.-Ing. Josef Fontaine, Dr. sc. techn. Hans-J. Manger
Anzeigenkontakt
VLB PR- und Verlagsabteilung
Tel. (030) 450 80-255 media@brauerei-forum.de
Erscheinungsweise
Erscheint mit zehn Ausgaben pro Jahr, zwei davon in Englisch.
Bezugskosten / Abonnement
Abonnement Inland 95 € inkl. MwSt. Ausland 95 € (zuzüglich Porto) Die Mindestvertragslaufzeit beträgt ein Jahr. Danach ist das Abonnement vier Wochen zum Monatsende kündbar.
Abonnements
Westkreuz Verlag, Berlin
Tel. (030) 7 45 20 47
Fax (030) 7 45 30 66 abo@brauerei-forum.de
Druck und Vertrieb
Westkreuz Verlag GmbH Berlin, Töpchiner Weg 198/200, D-12309 Berlin
Alle Rechte vorbehalten. Nachdruck, Ver vielfältigung oder Weiterverarbeitung, auch auszugsweise, ist nur mit ausdrücklicher Genehmigung der Redaktion und Quellenangabe gestattet. Für namentlich gekennzeichnete Beiträge übernehmen Herausgeber und Redaktion keine Haftung.
Hinweis der Redaktion: Um die Lesbarkeit unserer Publikation zu vereinfachen, verzichten wir weitgehend auf die zusätzliche Formulierung der weiblichen Form. Wir weisen aber ausdrücklich darauf hin, dass unsere Verwendung der männlichen Form als geschlechtsneutral zu verstehen ist.
Unsere nächste Ausgaben erscheinen am
31. Mai 2024 (englisch)
5. Juli 2024 (deutsch)
4th VLB Symposium on Acidic Fermented Non-Alcoholic Beverages
7./8. Mai 2024, Berlin
Bangkok Brewing Conference 2024
9. bis 11. Juni 2024, Bangkok, Thailand
IfGB Destillateur-Aufbaukurs 2024
10. bis 21. Juni 2024, Berlin
VLB-Sommerfest 2024
5. Juli 2024, Berlin
Mitgliederversammlung ehem. VLBer –Brewers of Berlin
5. Juli 2024, Berlin
14th Iberoamerican VLB Symposium Brewing & Filling Technology
2. bis 4. September 2024, Mexico City
Workshop „Craft Brewing in Practice“
9. bis 20. September 2024, Berlin
22. IfGB Forum Spirituosen und Brennerei
16. bis 18. September 2024, Vösendorf (A)
VLB-Oktobertagung 2024 – mit BraugerstenSeminar, Forschungskolloquium, SupplyChain-Management-Forum und Wassersymposium 7./8. Oktober 2024, Berlin
Mitgliederversammlung VLB Berlin e.V. 7. Oktober 2024, Berlin
Weiterbildung zum/zur Meister/in im Brauer- und Mälzer-Handwerk (HWK) 2024/2025
14. Oktober 2024 bis 4. Oktober 2025
Workshop „Micro Malting in Practice“ 13. bis 20. November 2024, VLB Berlin
Praxiskurs Mikrobiologie 2024
4 bis 8. November 2024, Berlin
Training Applied Microbiology 2024 18. bis 22. November 2024, Berlin
Certified Brewmaster Course 2025
6. Januar bis 27. Juni 2025, Berlin
EBC Congress & The Brewers Forum 2024 26. bis 30. Mai 2024, Lille, Frankreich
Brasil Brau 2024
11. bis 13. Juni 2024, São Paulo, Brasilien
Innovationstag Mittelstand des BMWK
13. Juni 2024, Berlin
Gesellschaft für Geschichte des Brauwesens (GGB), Mitgliederversammlung 2024
13. September 2024, Meschede-Grevenstein
BrauBeviale 2024
26. bis 29. November 2024, Nürnberg